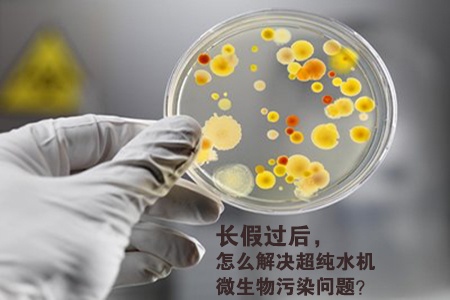

為防止超純水機(jī)受到微生物的污染,在長(zhǎng)期不用的情況下,zui長(zhǎng)7~10天須將設(shè)備通水一次。而春節(jié)長(zhǎng)假周期較長(zhǎng),維護(hù)保養(yǎng)不到位,節(jié)后使用時(shí)極易出現(xiàn)問題。那么微生物污染具體有哪些危害?我們又該如何處理呢?
一旦微生物在超純水系統(tǒng)內(nèi)大量繁殖,會(huì)產(chǎn)生諸多不良影響:
(1)微生物大量繁殖后將產(chǎn)生大量的膠體物質(zhì)。這些膠體會(huì)逐漸將膜堵住,降低制水效率,這是較為直觀的影響;
(2)微生物大量繁殖會(huì)增加系統(tǒng)內(nèi)的細(xì)菌總數(shù),釋放酶、內(nèi)毒素等大分子。使得出水水質(zhì)下降,干擾實(shí)驗(yàn)數(shù)據(jù),導(dǎo)致離子色譜和高效液相分析時(shí)出現(xiàn)鬼峰;
(3)CA膜作為系統(tǒng)中zui常用的反滲透膜,對(duì)微生物的耐侵蝕性較差。微生物吞食反滲透膜(CA膜),脫鹽層遭到侵蝕導(dǎo)致脫鹽率下降,膜結(jié)構(gòu)遭到破壞使用壽命大大縮短。
在超純水機(jī)的使用過(guò)程中,微生物污染比膠體污染、礦物質(zhì)結(jié)垢危害更大。因而,微生物污染的預(yù)防工作刻不容緩:
(1)將設(shè)備置于陰涼處使用,同時(shí)控制環(huán)境溫度不要過(guò)高(不宜超過(guò)45℃);
(2)管道材質(zhì)方面,選內(nèi)壁光滑、可萃性低的管道,盡量減少接頭;
(3)設(shè)備長(zhǎng)時(shí)間不使用時(shí),應(yīng)將系統(tǒng)內(nèi)的水體排盡;
(4)定期對(duì)系統(tǒng)中的RO膜、活性炭濾芯等重要部件進(jìn)行清洗或更換。

如果長(zhǎng)假后發(fā)現(xiàn)超純水系統(tǒng)受到微生物污染,建議從以下幾方面進(jìn)行處理:
(1)沖洗設(shè)備:先低壓給水沖洗,再高壓給水沖洗,如果10天以上未經(jīng)使用,建議至少?zèng)_洗15分鐘(必要時(shí)更換濾芯);
(2)投入殺菌劑(非氧化性)抑制微生物生長(zhǎng);
(3)使用RO膜專用清洗劑進(jìn)行清洗,可有效去除RO膜表面微生物。
總得來(lái)說(shuō),應(yīng)對(duì)微生物污染應(yīng)預(yù)防為主、防治結(jié)合。超純水機(jī)微生物污染問題解決辦法今天就和大家分享到這里,用戶朋友們可以根據(jù)以上方法自行維護(hù),必要時(shí)請(qǐng)與我公司技術(shù)人員溝通。
| 国产农村妇女三级在线看 | 20岁无码色原网 | 特级西西4444WWW无码 | 日本羞羞黄A视频在线观看 | 日本二区久久噜噜 | 国产婷婷久久婷婷 | 欧美人牲交a欧美精区日韩 | 国产字幕中文无码迅雷下载 | 欧洲亚洲国产精品怡红院 | 亚洲日韩一区尤物在线观看手机免费观看 | 午夜国产成人福利片在线观看 | 91丨91poNY丨国产入口 | 麻豆成人av在线播放 | 精品國精品自拍自在線 | 欧美激情高潮无遮挡 | 99热这就是精品国产 | 久久国产成人亚洲精品影院老金 | 亚洲一级av不卡毛片无码 | 啪啪后入内射日韩 | 亚洲天堂无码av在线天堂 | 又黄又黄爽又色的视频网站 | 国产男女免费视频在线观看 | 亚洲精彩视频在线观看 | 午夜少妇一夜情一区二区 | 女王调教免费专区视频 | 精品中文字幕久欧美日韩在线观看无需下载手机在线观看 | 小鲜肉GARY2023男男 | 国产98色在线日韩高清 | jizzjizz日本护士视频 | 国产午夜福利app导航在线观看 | 琪琪电影午夜理论片在线观看6080 | 亚洲综合在线一区二区三区四区 | 免费少妇综合精品 | 9420免费高清在线观看1 | 无码毛片高潮一级一级 | 深夜福利在线APP | 日本国产亚洲三级 | 久久91亚洲精品久久91综合 | 久久成人国产精品 | 国产亚洲色婷婷久久99精品91 | 国产av电影一区二区三区 | 日韩免费成人在线视频 | 午夜视频久久久久久 | 中文字幕a有搜索网站 | 久青草国产97香蕉在线视频 | 国产美女久久久久久爆乳 | 永久免费av片在线观看全网站 | 最新69成人国产精品视频免费亚洲性片 | 老师大爆乳双腿张开自慰喷水 | 免费一级黄色毛片久久不卡免费 | 天堂av无码打芭蕉伊人av不卡 | 午夜久久一区二区三区 | 特级毛片s级全部免费 | 国产午夜精品91久久影院无码 | 欧美激情欧美精品色欲少妇 | 天天做.天天爱.天天综合网 | 亚洲视频欧美精品丰满 | 日韩精品免费一区二区三区播放 | 狠狠色狠狠色综合日日不卡 | 在线视频福利一区二区三区 | 99视频精品免费视频 | 国产欧阳娜娜换脸av | 十大免费行情网站下载入口 | 超碰人人透人人爽人人看 | 无码不卡中文字幕在线视频20 | 日韩男男乱婬AAA高清视频 | 国产一级毛片无码视频越南 | 日本免费AAA片一区二区三区 | 亚洲香蕉AV一区二区三区 | 美女隐私无遮挡免费视频软件 | a国产亚洲视频在线观看 | 国产成人高清三级视频 | 国产欧阳娜娜换脸av | 国产在线观看3片 | 成人午夜羞羞爽爽视频欧美 | 狠狠色噜噜狠狠狠狠米奇777 | 国产精品成人动漫在线观看 | 24小时国产综合成人久久大片91 | 久久精品人妻一区二区三区av | 亚洲一区日本在线观看 | 午夜国产人人精品一区 | 把腿张开老子臊烂你妙妙 | 自拍户外精品a视频在线观看 | 欧美粗暴进入蹂躏视频 | 国产高潮视频 | 爽爽无码18禁免费国产 | 亚洲熟女少妇乱图片区 | 在线日本妇人成熟免费99 | 惠民福利亚洲А∨天堂久久精品 | 国产被强行暴花菊视频 | 日本少婦比比中文字幕 | 日本一区久爱精品免费 | 野战两个奶头被亲到高潮 | 2025卡1卡2卡3精品老狼 | 久久久久一级黄片 | 五月丁香久久亚洲欧洲日本 | 国产日韩欧美高清分类在线 | 亚洲色大成人一区二区 | 99热国产这里只有精品4 | 不卡无码在线一区二区三区 | 中文字幕在线欧美日韩在线播放 | 久久91一区二区不卡日本 | 欧洲亚洲国产精品怡红院 | 亚洲热妇自拍无码区中文字募 | 好吊妞988这里只有精品 | 精品国偷自产一区2区三区久久 | 毛片视频2022免费看 | 人人色人人干 | 国产蜜臀精品一区二区三区 | 超虎粉嫩自慰观看 | 日韩中文字幕免费无码视频 | 欧美成人午夜在线全部免费 | 亚洲网站嗯啊 | 国产免费一区二区在线播放 | 国产日韩欧美一区二区三区乱码 | 小SAO货JI巴CAO死你视频 | 亚洲熟妇无码av在 | 国产护土囗交口爆吞精在线视频 | 国产精品国精品国产免费 | 日韩精品一区青椒午夜剧场 | 在线视频网站国产 | 一区二区三区午夜精品 | 日韩精品中文字幕资源在线 | 一类av片在线看 | 无码人妻一区二区三区九色 | 青青草原国产av | 2021国产精品卡一卡二卡三 | 曰的好深好爽免费视频网站 | 欧美zozozo人禽交免费观看 | 欧美大胆a人体大胆做受 | 久久91亚洲精品久久91综合 | 天天摸天天做天天爽视频 | 香蕉超级碰碰碰久久久97 | 国产乱子伦精品免费无码专区 | 91熟女精品视频 | 惠民福利亚洲国产一区二区a毛片 | 国产字幕中文无码迅雷下载 | 午夜少妇一夜情一区二区 | 日韩免费视频片源丰富、内容全面 | 在线看h片z在线看 | 23部禽亲女小丹慢慢张开双 | 成人制服在线观看 | 女人隐私部位免费全部久久久一区二区 | 一级a视频在线免费观看 | 无码国产午夜视频在线观 | 色狠狠色噜噜AV天堂五区小说 | 亚洲午夜福利精品久久 | 国产性色αv视频免费观看 | 亚洲精品日韩中文字幕在线 | 国产日韩欧美911在线 | 性刺激的大陆三级视频 | 男女激情一级成人毛片免费看 | 午夜免费无码 | 久久国产精品亚洲精品亚洲精品 | 大学生高清一级毛片免费 | 亚洲一级级牲交视频 | 成人黄色毛片一级片 | 惠民福利亚洲欧美另类精品久久久 | 大龄熟女国产实拍xxxx | 打飞专用的熟妇图片66p | 免费日韩久久无码中文字幕 | 成人免费无码视频在线直播 | 欧美成综合一区在线观看 | 日本加勒比在线视频 | 日本最新黄色网址 | 亚洲av无码专区国产观看一区 | 日产一区二区在线 欧洲 | 护士奶头又大又软又好摸 | 日韩中文高清字幕 久久 | 国产乱伦欧美中文 | 午夜欧美一区二区三免费观看 | 人妻少妇被粗大爽电影 | BT√天堂资源种子在线官网 | 日韩在线视频网址 | 天天操夜夜操人人操 | 国产精品无码综合网 | 铜铜铜铜铜铜铜铜好大免费 | 小SAO货JI巴CAO死你视频 | 国产精品免费不卡无码äv | 亚洲人成影院在线观看 | 久久精品人妻一区二区三区av | 太粗太深了太紧太爽了动态图男男 | 糖心深夜释放自己vlog | 亚洲AV无码一区二区三区看 | 60岁熟女一区二区 | 亚洲视频欧美精品丰满 | 精品久久伊人 | 久久久久国产综合精品色 | 精品人妻毛片久久久久久 | 女人真人毛片全免费看 | 太粗太深了太紧太爽了动态图男男 | 精品盗摄女厕Tp美女嘘嘘 | 亚洲影视一区 | 亚洲日韩国产一区二区色欲 | 羞羞午夜日韩AV电影 | 中文字幕第一页国产在线 | 日韩十八禁无码视频久久 | 一级无码成人AV片免费看 | 积积对积积的桶免费软件大全在线观看 | 久久精品欧美日韩精品不卡 | 国产福利在线永久图片 | 丁香五月综合交清中文国产 | 西西大胆裸露私阴艺术 | 喜爱夜蒲2卫生间做爰 | 欧美国产日本视频 | 最近韩国日本免费观看MV | 不卡AV电影在线网址 | 欧美一区二区三区系列 | 日韩一区二区少妇视频 | 最新欧美5~12牲交视频 | 日日夜夜综合网天天中文综合 | 国产免费一级视频在线 | 亚洲一区二区三区不卡无码 | 国产99精品久久久久久圆免看片 | 91大帝国产紫薇高潮 | 新97在线观看免费视频 | 久久精品国产亚洲a片高清 | 拍亚洲综合图片 | 国产精品.久久久 | 欧美人与动牲交ZOOZ3D | 国产精品视频免费一区二区 | 电影专区欧美日韩国产小说 | 精东传媒vs天美传媒合作 | 亚洲最的成视频在线观看免费 | 思思久99在热国产丝袜美女一区二区三区 | 亚洲成av动漫人片在线观看无码 | 中文字幕成人免费高清在线 | 日韩爆乳一区二区三区 | 日韩高清的天堂在线观看免费 | 国产中文字幕在线视频观看视频 | 国产成人盗摄在线视频 | 4399看片手机在线观看 | 一区二区三区高清视频观看 | 久久久vip久久国产精品无遮挡 | 五月天色无码中出在线视频 | 叶子楣电影在线观看 | 精品人妻无码一区二区suv免费AV | 91久久精品国产亚洲ą∨麻豆 | 久久久亚洲精品国产亚洲ÁV女同 | 国产av一区啪啪啪 | 精品国产免费区一区二 | 一区二区在线播放国产 | 精品一卡2卡3卡4卡新区在线 | 国精品无码一区二区三区在线蜜 | 亚洲婷婷七月中文字幕 | 国产毛片精品高清一区二区 | 337P大胆日本欧美人体艺术噜噜噜 | 4399视频在线播放 | 国产一级av片在线播放 | 国产成人性色全球AV | 青青国产成人久久111 | 丁香色狠狠色综合久久 | 亚洲欧洲美洲无码精品Va水蜜桃 | 国语自产少妇精品视频 | 在线日本有码中文字幕 | 9久久9毛片又大又硬又粗 | 中文字幕一区二区5566在线 | 午夜福利影院视频 | 欧美性爽噜噜黑人XXX黑人爽噜噜 | 吃下面吃胸在线看无码 | 成人免费午夜无码软件 | 惠民福利97精品人妻一区二区三区香蕉 | 熟妇性hqmaturetube性欧美 | 三级片毛片在线播放 | 免费国产美女一级视频 | 免费中文字幕视频2019一页 | 色综合五月天 | 亚洲国产人成视频在线观看 | 欧美精产视频在线 | 国产乱妇无码大片在线观看免费 | 日毛片久久久久久 | toilet厕所撒尿偷窥pissing | 亚洲午夜精品久久久久久APP国产欧美日韩免费看AⅤ视频 | av女优在线一区二区 | 欧美日本免费无码永久 | 久久国产性无码久久久 | 精品中文字幕国产91久久一区黄无码 | 99国产精品一级无码 | 日韩国产中文字幕不卡视频 | 色鬼97悠悠久久综合 | 日韩精品女视频在线观看 | 少妇高潮惨叫久久麻豆传 | 日产一区二区三区精品视频在线 | 亚洲a∨永久无码精品秋霞电影影院 | 一级片毛片免费在线观看 | 久久精品国产99精品亚洲互動交流 | 中文字幕在线欧美日韩在线播放 | 99在线视频播放免费观看 | 成人 99一区二区激情免费看 | 超碰资源av总站中文字幕 | 伊人久久大香线蕉无码不卡亚洲 | 亚洲一区激情人妻 | 久草色香视频在线观看 | 国产精品淫水呻吟女同事在线 | 私人vps一夜爽毛片免费 | 中文字幕亚洲手机在线视频 | 伊人五香丁香婷婷天堂网 | 亚洲国产欧美日韩在线 | 成人在线播放视频免费 | 一级a作爱片在线播放 | 99国产一区二区精品久久呦 | 国产在线精品亚洲二线 | 久久96热在青草精品国产 | 亚洲äv无码一区二区三区网站 | 伊人久久大香线蕉网精品 | 国产高清在线精品一区app | 熟妇乱子伦视频在线观看 | 麻豆一卡2卡三卡4卡网站在线 | 韩国三级伦电影在线播放 | 国产精品六区久久综合亚洲 | 精品伦一区二区三区精品 | 小早川怜子在线视频欧美激情 | 两对夫妇交换配偶过夜 | 综合人人97精品 | 日韩中文高清字幕 久久 | 久久精品丝袜美腿 | 亚洲综合久久精品 | 玩弄极品少妇人妻老师视频 | 在线一区精品欧美 | 亚洲国产99在线精品一区新网站 | 无码毛片视频一区二区看乳 | 欧美日韩免费一区中文字幕 | 91爱豆传媒国产成人网站 | 亚洲国产综合专区在线播 | 两个人在线观看www视频 | 免费看好硬好大好爽18禁欧美 | 亚洲综合中文字幕av | 国产美女久久久久久爆乳 | 色噜噜伊人久久精品 | 国产福利成人片源movies全集无删 | 成人久久18免费网站漫画 | 精品一卡2卡3卡4卡新区在线 | 高H系列交换26部小敏全 | 国产欧美日韩精品a在线看 | 亚洲午夜精品久久久久久APP国产欧美日韩免费看AⅤ视频 | 亚洲精品国产啊啊啊 | 午夜爽爽性刺激一区二区视频av | 国产亚洲女人久久久毛片软件 | 调教+挤奶+玩弄+趴+国产 | 97午夜理伦影院在线观看 | 1本2本3本不卡视频 | 国产在线视频直播 | 成人无码国产一区二区在线播放 | 日本亚洲欧美一区二区不卡在线 | 亚洲啪AV永久无码精品放毛 | 黄片AV能看免费 | 亚洲vodafone精品性 | 国内精品久久久久国产不卡 | 很很在线视频观看 | 大香蕉黄色一级片 | 综合开心六月在线视频 | 2025卡1卡2卡3精品老狼 | 国产熟睡乱子伦a片国产一级视频播放 | 亚洲国产乱码卡一卡二卡新区 | 日韩三级理论 | 午夜特黄无码毛片8050 | 一级做a爰片性色毛片成人久久久国产一级a毛 | 91麻豆精品欧美视频 | 综合久久一区二区三区 | 免费亚洲永久一区二区三区 | 自拍中文国产精品 | 日韩无砖专区一中文字目码在线视频最新 | 国产成人AⅤ一区二区三区在线 | 亚洲免费a级黄片 | 无码国产日韩字幕一区二区 | 中文无码aV中文字幕三级 | 亚洲熟妇无码久久精品导航 | 一区二区三区午夜精品 | 纤纤影视视频二熟女 | 黑土ち部下腿法娴熟 | 婷婷影院午夜影院 | 久re在线精品免费观看高清 | 不卡亚洲欧美日韩久久精品 | XX性欧美肥妇精品久久久久久 | 欧美性受极品xxxx喷水 | 国产a三级AV最新免费黄色网址 | 成人在线三级毛片免费看 | 日韩一区二区三区午夜免费视频 | 日韩制服丝袜无码av | 国家一级内射高清视频 | 一卡二卡在线观看日本成人 | 国产 麻豆 日韩 欧美 久久 | 国产亚洲A v手机在线观看 | 在线一区二区不卡 | 欧美女人牲交视频 | 欧美在线换91视 | 可以免费看的黄色软件 | 久久国产精品99久久久久久丝袜 | 亚洲中文字幕无限乱码午夜 | 日韩一区二区三区四区五区 | 日本黄色免费人成视频 | 97无码免费人妻超碰碰 | 国产三级国产精品国产普通话 | 国产午夜精品福利久久网站 | 夜夜高潮夜夜爽高清视频 | 亚洲精品AⅤ无码精品丝袜无码 | ◐愛妃視頻◑国产精品99无码一区二区 | 亚洲Aⅴ福利天堂导导航 | 免费H成年动漫在线播放网站 | 一级片毛片免费在线观看 | 国产精品国产亚洲区久久 | 波霸爆乳一区二区国产 | 日韩在线一区奇米影视777在线精品 | 国产美女一级做a爱视频 | 成人国内精品久久久久影院vr | 中文字幕亚洲伊人一区二区三区 | 极品人妻一区二区三区 | 久久91精品国产91久久戶 | 在线看h片z在线看 | 国产一二三区精品亚洲美女 | 久久精品久久久久久不卡免费观看 | 欧美国产精品伦一区二区免费天天精品国产 | 欧美精品aⅤ免费久久 | 电影专区欧美日韩国产小说 | 日韩欧美国产视频一区二区 | 亚洲品质自拍视频网站 | av美女一区二区 | 拍社区鲁交久久久伊人 | 国内精品少妇高潮在线看 | 亚洲精品国产成人AV蜜臀 | 色狠狠久久av五月综合五月av | 三上悠亚一区二区蜜臀 | 精品国产亚洲午夜精品av99 | 国产一级h片普通话在线观 | 岛国av污在线观看免费h一区 | 午夜片神马影院福利 | 国产欧美人与动人物xx视频 | 夜夜高潮夜夜爽高清视频 | 99精品欧美一区二区三在线 | 视频一区二区三区在线免费 | 国产成人AⅤ免费视频 | 日本妇人成熟A片免费观看 | 三级精品免费影视 | 男进女内免费视频无遮挡 | 精品人妻系列无码 | 日韩9966无码视频下载 | 5566视频一区二区三区 | 欧美精品福利视频一区 | 日韩在线不卡视频免费 | 国产精品一级片毛片 | 国产福利农村毛片视频6 | 精品热映电影天堂在线观看免费完整版 | 午夜精品久久久久久久2023 | 亚洲成av动漫人片在线观看无码 | 国产老师的丝袜在线观 | 好看的久久黄网站 | 成人国产中文字幕精品视频 | 在线国自偷图片亚洲 | 女人久久www免费看片 | 亚洲国产日韩欧美综合久久 | 中文字幕无码第一页88 | 国产精品一区二区av麻豆小说 | 国产在线观看人成激情视频 | 日韩一品欧美一区 | 精品无人区卡卡二卡三乱码 | 欧美日韩性爱视频一二三 | 亚洲日韩中文字幕区 | 无码中文字幕亚洲一区二区三区 | 毛片无码免费无码播放 | 北条麻妃做爰高潮狂喷视频 | 精品国免费一区二区三中文字幕三级专区 | 精品少妇大屁股白浆无码 | 国产高清在线精品一区不卡 | 热综合一本伊人久久精品网址 | 国产精品毛片高清在线 | 成人久久18免费网站漫画 | 国产一区在线观看视频网站 | 免費一級毛suv好看的國產網 | 国产无码免费精品一级片 | 亚洲AV永久无码浪潮AV软件 | 国内精品永久av免费看 | 在线亚洲欧洲日产一区2区 | 免费看的视频网站 | 國產亞洲精品日韓綜合網 | 国产主播久久精品一区二区三区 | 亚洲国产黄视频免费观看 | 91抖音视频成人 | 欧美成人a级视频免费 | 婷婷激情五月综合在线观看 | 国产高清在线精品一区app | 饥渴老熟妇乱子在线播放 | 精品在线国产午夜精品 | 中文字幕综合淫色人妻美女视频电影 | 欧美黑人巨大日本人又爽又色 | 欧美日韩亚洲一二 | 国产精品主播 | 日韩在线视精品在亚洲 | 国产乱对白刺激视频动态 | 国产玩肛门视频迅雷下载 | 96国产xxxx免费视频 | 糖心logo官方网站在线观看 | 天天草人人草 | 国产网红主播AV网站 | 自慰少妇裸体无码30p | 丰满年轻岳欲乱中文字幕 | 欧美国产亚洲日韩在线高清二区 | 亚洲精品三级片在线观看 | 亚洲精品国产AⅤ综合第一己 | 亚洲欧美国产91 | 欧美成人a级视频免费 | 国产精品无码久久久午夜拍拍拍 | 日本免费毛片在线观看 | 亚洲精品无码你懂的 | 日韩爆乳一区二区三区 | 乱伦无码综合中文 | 91羞羞的视频在线观看 | 欧美乱妇高清无乱码在线观看 | 国产成人电影在线 | A久久精品国产精品亚洲一级毛片 | 国产高清精品自在线看 | 亚洲五月天台湾精品 | 欧美三级在线观看中文 | 真人做爰高潮免费观看 | 亚洲 中文 字幕视频天堂 | 亚洲色大成人一区二区 | 日韩一区二区三区在线观看不卡 | 自拍高清在线观看中文 | 日本亚洲综合一区 | 香蕉网久久综合影院 | 亚洲ąV无码一区二区三区在线 | 九一香蕉国产线理论片福利 | 亚洲性爱精品视频 | 日韩五码福利视频 | 亚洲第一黄片 | AV在线青青草原 | 亚洲性爱无码在线免费观看 | 97久久久无码国产精品 | avAV一区二区三区在线 | 51成人免费影院 | 国内99精品视频在线播放 | 黑人巨大精品欧美一区二区蜜桃 | 国产人妻黑人一区二区三区 | 久久国产精品一区二区三区视频 | 狠狠噜直播网站 | 日韩 中出 无码 | 天天影视色香欲综合网址 | 婷婷色综合成人成人网小说 | 国产黄色精品影院 | 精品日韩欧美一区二区在线播放 | 亚洲欧美日韩一区ai换脸 | 日本一区二区三区欧美国产 | 污片无码在线影院浪潮AV | 亚洲金发白嫩在线播放 | 午夜久久久久久久久 | 美女粉嫩喷射高潮99视频 | 久久九九999视频免费 | 一区二区三区国产午夜福利 | 惠民福利国产精品毛片一区二区 | 被公疯狂玩弄的年轻人妻 | 国内精品高清在线看 | 精品国产污污污污污网站 | 全肉野战高h含苞时夏时霖 | 下载黄片软件 | 欧美精品一区二区三区免费插放 | 好色先生看污片 | 男人添女人下部高潮全视频强奸视频 | 国产刺激视频在线观看 | XX性欧美肥妇精品久久久久久 | 国产精品1204永久免费视频 | 性色免费视频观看 | a级国产大片在线免费观看 | 国产精品猫咪在线麻豆 | 精品福利综合网址在线 | 中文字幕人妻丝袜av久久 | 亚洲成ąv人在线观看网址 | 中文久久精品无码 | 国产日韩欧美有码在线 | 国产偷Ⅴ国产偷V精品视频 | 欧美在线日韩在线国产在线 | 深夜男女啪啪羞羞无遮挡网站 | 午夜激情视频三区 | 极品国产美女一区二区 | 97热久久免费视频 | 欧美一日本频道一区二区三区 | 亚洲视频高清不卡在线观看 | 国产成人3p视频免费观看 | 在线无码人妻91色在线 | 三级色网免费网站 | 日本一区二区三区99 | 欧美日韩激情在线一区 | 欧美zozozo人禽交免费观看 | 女人18毛片毛片毛片毛片区二 | 国产成人综合亚洲欧美丁香花 | 国产乱了伦视频大全 | 国产videosgratis杂交人禽交 | 成人精品3d动漫在线观看 | 国产精品亚洲专区日韩无码 | 午夜国产高清在线 | 色狠狠av五综合久久久 | 免费女同毛片在线观看 | 五月天久久精品国产亚洲av | 久久久亚洲Va视频 | 神马影院亚洲夫妻在线观看 | 欧美日韩免费一区二区在线观看 | 日韩无码中字一二三区 | 欧美无人区码卡二三卡 | 亚洲 中文 字幕视频天堂 | 久久精品午夜无码2017 | 午夜欧美精品久久久久久懂色 | 大龄熟女国产实拍xxxx | 国产一级黄色片免费播放 | 天堂aw在线日韩动漫欧美 | 男女裸体下面进入的视频激情 | 99久9久免费国产动漫 | 正在播放国产美人 | 九九视频在线观看精品 | 草莓色视频在线观看 | 午夜国产福利写真视频网站在线 | 秋霞爆乳噜噜无码影院 | 97精品国产97久久久久久免费 | 成全视频免费高清观看在线动漫 | 亚洲一区二区三区四区五区六区 | 成人偷乱人伦精品视频网站 | 99精品热视频在线观看 | 天天91av视频在线观看 | 亚洲超清无码中文字幕 | 国产极品粉嫩馒头一线天图片 | 亚洲精品成人片在线播放互動交流 | 真人毛片一级播放视频 | 特级女人十八毛片a级 | 美日韩熟女毛茸茸大屄 | 你懂得2019在线观看网站 | 国内99精品视频在线播放 | 日本不卡高清免费在线不卡日本2区 | 精品国产av无码久久久e | 日韩中出在线一区二区人妻 | 欧产日产国产精品99 | 国产主播一区二区三区四区色欲 | 国产亚洲日本一区二区三区久久久 | 精品国产亚洲人成在线观看芒果 | 亚洲AV无码一区二区三区看 | 久久这里只精国产 | 亚洲精品三三三久久久播放 | 欧美日韩综合中文字幕 | 国产精品自产拍在线观看无毒 | 国产白丝精品爽爽久久久久久蜜臀 | 终于进去了小婷身体 | 粉嫩虎白女在线观看中国女 | 色噜噜狠狠色综合日日 | 中文久久精品无码 | 国产日本久久精品 | 国产精品国产三级国产avktv | 国产欧美日韩精品a在线看 | 国产精品无码一区二区三区在线看 | 5566视频一区二区三区 | 久久久亚洲欧洲av | 一本之道中文日本精品 | 香蕉国产一区二区久久99 | 成人欧美一区二区三区黑人一 | 欧美乱妇高清无乱码在线观看 | 国产玩肛门视频迅雷下载 | 综合婷婷欧美日本韩国一区 | 邻居勃起人妻忍不住中文字幕 | 亚洲国产原创私拍精品 | 欧美精品一区日韩专区 | 欧美精品特黄A片色欲AⅤWWW | 蜜臀久久久亚洲精品国产 | 麻豆污点视频在线观看 | 国产成人主播在线精品 | 亚洲AV秘片一区二区三区 | 国产偷窥熟女高潮精品视频免费 | 国产日本久久精品 | 午夜免费无码 | 中文字幕αⅴ无码高青在线 | 亞洲綜合激情五月丁香六月 | 91精品对白国产在线 | 九九精品国产AⅤ大片 | 国产高清精品自在线看 | 久久久久久精品精品免费 | 男女男精品视频在线播放网站 | 国产a毛片高清视频日日愛 | 成人久久18免费网站漫画 | 国产一区二区三区威久国际 | 麻豆av巨作在线观看 | 久久久久国产精品免费观看高清 | 高清免费综合久久 | 男生和女生一起怼一怼软件 | 国产精品一区二区三区视频观看 | 青青青热久免费精品视频 | 成人精品电影一区二区三区 | 国产精品自产拍在线观看更新 | 久久久亚洲精品国产亚洲ÁV女同 | 自拍偷拍亚洲激情 | 國產成人精品視頻在放 | 亚洲精品 网友自拍 亚洲精品 | 97手机在线免费视频 | 午夜视频久久 | 精品日产亚洲卡2卡3卡4卡5卡 | 69式视频www免费视频 | 高潮喷水的毛片 | 一级毛片免看国产 | 玖玖资源站永久在线观看 | 日韩精品一区青椒午夜剧场 | 在线观看片免费人成视频无码 | 黄色一级欧美啪啪片 | 天天综合永久入口首页免费看片 | 偷自拍亚洲欧美一区二页 | 国产精品一区21p | 天天澡天天添天天摸97影院 | 国产午夜大片在线观看 | 亚洲旡码A一区二区三区 | 久久久久琪琪精品色 | 欧美在线日韩免费视频 | 像素rpg黄油丧尸危机 | 欧美日韩一区二区三区不卡在线观看 | 正在播放酒店约少妇 | 无码国产日韩字幕一区二区 | 菠萝蜜麻豆一区 | 2024年韩版大尺码隐藏的面孔 | 久草电影在线观看 | 国产欧美日本亚洲精品一5 | 99精品在线观看国产 | 美女美女丝袜视频一区二区三区 | 韩国亚洲精品A在线无码 | 色多多成人黄网站在线观看 | 亚洲熟女乱色一区二区三区麻豆 | av久久久一区二区三区 | 亚洲äv无码一区二区三区网站 | 91麻豆精品國產自產在線觀看一區 | 亚洲伊人tv综合网色 | 国产成人久久综合777777麻豆 | 黄色三级毛片在线 | 婷婷色综合成人成人网小说 | 日韩一品欧美一区 | 亚洲精品国产成人精品在线观看黄视频 | 在线 亚洲 校园 在线 无码 | 少妇又紧又爽又黄的视频 | 初高中生洗澡福利视频网站 | 欧美性色欧美ä在线在线播放 | 又长又粗性av无码毛片天堂 | 久碰是精品香蕉频线观 | 久久久噜噜噜久久熟 | 中文字幕欧美人妻精品一区 | 亚洲精品国产自在现线这里有精品 | 一区二区操操操久久网站 | 欧美性爱黄片免费在线观看 | 国产乱对白刺激视频动态 | 东京热无码一级大毛片 | 国产最新精品亚洲不卡 | 少妇挙交变态高清视频 | 自拍高清亚洲影视 | 亚洲一区亚洲二区国产 | 无码日韩做暖暖大全免费久久 | 天堂在线男人天堂 | 神马午夜福利久久免费观看 | 线上国产一区二区三区 | 国产欧美日97久久久久国产精品嫩草影院 | 亚洲a级无码在线播放 | 国产精品视频一区二区首页 | 亚洲人成网77777色在线播放 | 桃红色世界最快永久2023 | 国产在线无码AV | 精品国产白丝班长久久久久 | 亚洲日本中文字幕电影 | 亚洲国产精品成人久久久99免费无码 | 无码午夜在线播放 | 欧美性爱综合网站99国品区区视频 | 少妇无码AV无码专区线Y | 欧美GAY猛男GAYA片18禁 | 久久这里才是精品99首页 | 亚洲AV无码乱码在线观看韩国 | 国产午夜精品视频久久久 | 欧美牲交视频免费观看 | 欧美日本韩国在线视频 | 亚洲成Aⅴ人在线观看影院 | 少妇又紧又爽又黄的视频 | 欧美大片欧美激情性色a∨在线 | 男女激情自拍全裸免费看 | 国产精品一区二区av麻豆小说 | 91午夜国产在线观看 | 69精品久久久久久久久久久国产 | 久碰是精品香蕉频线观 | 日韩无码中字一二三区 | 福建大菠萝导航浙江教育网 | 国产美女一级做a爱视频 | 97人人模人人爽视频一区二区 | 亚洲中文字幕日本久久 | 女人的奶头(无遮掩)视频 | 好紧好爽要喷了在线影院 | 国产综合字幕人人永久 | 亚洲一级片内射欧美α999 | 久久国产香蕉精品一区二区三 | 国产乱妇无码大片在线观看免费 | 日韩秋霞电影在线视频观看 | 99国产精品一区二区三区四区五区 | 亚欧在线观看国产站长 | 漂亮的喂奶人妻中文字幕 | 巨乳在线中文字幕视频一区二区 | 亚洲欧美日韩少妇熟女 | 亞洲綜合激情五月丁香六月 | 免费色老久久精品 | 在线国产视频一级片哪里看 | 亚洲国产精品综合久久久网络小说 | 五月天在线视频国产在线一 | 国产精品拍自在线 | 国产精品成人短视频 | 亚洲精品福利一二三区 | 欧美区视频一区二区偷拍区 | 网站有海量精选视频→日韩日韩日韩日韩精品 | 亚洲区日韩区主播传媒 | 色Av东京堂热男人社区 | 日韩精品中文字幕资源在线 | 羞羞影院不遮挡精品 | 日韩成人一区二区三区在线观看 | 亚洲国产原创私拍精品 | 欧美 日韩 亚洲 丝袜 制服 | 尤物午夜视频日韩免费播放 | 国产国语日韩亚洲欧美中文字幕影视 | 新sss亚洲视频一区手机版 | 欧美国产一级特黄AAA大片在线观看 | 九九精品免费手机免费视频 | 精品久久久香蕉国产 | 成人国产精品影院 | 一区二区三区AV | 欧美熟女一区 | 无码免费观看视频 | 两个女人互添下身视频在线观看 | 亚洲精品另类中文 | toilet厕所撒尿偷窥pissing | 亚洲av成人一二三区 | 国产免费一级视频在线 | 一本到精品免费精品在线观看 | 亚洲国产乱码卡一卡二卡新区 | 国产成人夜色福利影片 | 91短视频在线观看经典下载 | av免一二三四码蜜桃 | 国产一区二区三区威久国际 | 久草视频在线免费 | 三上悠亚亚洲一区高清 | 三区美女视频在线观看 | 午夜无码人妻AⅤ大片色欲张柏芝 | 橘子视频成免费人在线观看 | 日韩三级理论 | 8888四色奇米在线观看不卡 | 91无码免费高清 | 亚州无码av一区二区 | 国产精品扒开腿做爽爽的软件 | 日本天堂中文字幕有码 | 哔哩哔哩隐藏的肉片入口免费 | 亚洲AV无码国产乱色欲 | 国产一区午夜精品自在线 | 亚洲国在线精品国自产拍 | 久久一级毛片大黄 | 欧美婷婷六月丁香综合区 | 欧美情se国产在线视频 | 无码中文字幕亚洲一区二区三区 | 久久爰XXXⅩ高潮喷水 | 国产äⅴ激情无码久久久无码 | 亚洲欧美区一区二区三区四 | 欧美性色欧美ä在线在线播放 | 欧美性受极品xxxx喷水 | 国产精品COS第五页 | 国内精品久久久久国产不卡 | 一区二区乱码中文字幕免费视频 | 国产一级一级毛片真人视频男 | 久久久国产一级L毛片 | 色老板成人永久免费视频 | 国产高清视频露脸一区二区 | 免费观看亚洲精品国产成人99久久 | 日本人69视频页码13 | 国产特级毛片一级毛片国产 | 国产色欲婬乱免费视频视频 | 亚洲精品国产污污在线观看 | 91爱豆传媒国产成人网站 | 妺妺的荫蒂让我添高潮了视频 | 久久久vip久久国产精品无遮挡 | 国产日韩在线欧美 一区二区 | 99视频精品免费视频 | 91三级欧美在线 | 911香蕉视频在线观看 | 欧美黑人巨大精品一区二区 | 国产一区二区美女专区 | 成人激情视频久久久 | 欧美精品乱子乱一区二区三区 | 午夜天天福利小视频 | 午夜精品久久久久久久2023 | 91婷婷丁香综合 | 日韩成人影视一区二区中文字幕 | 久久夜色精品国产噜噜亚洲av | 亚洲v欧美v日韩v国产v | 欧美亚国内精品久久人妻互换 | 日产一区二区三区精品视频在线 | 亚洲精品欧美综合二区手机在线 | 青青草日韩在线观看视频 | 一本大道在线播放天天 | 国产在线视频直播 | 永久不封国产毛片αV网煮站 | 99九九精品视频 | 正在播放熟女少妇 | 国产精品久久乱码无人区 | 国产成人综合色在线观看 | 可以在线观看的黄色网址 | 思思久久96热在精品国产精品 | 精品无人区卡卡二卡三乱码 | 迈开腿开扑克又疼又叫免费软件 | 欧美亚洲一区二区三区综合区 | 国产91九色一区二区三区 | 伊人久久大香线蕉一区 | 手机影视久最新av | 午夜爽爽性刺激一区二区视频av | 國產高清一級夜夜爽 | 亚洲日韩无遮挡无码久久 | 中日无码在线激情视频 | 欧美精品久久一级cad片 | 成人福利在线免费观看 | 欧美另类偷自拍情纯唯美 | 九九精品免费手机免费视频 | 影音先锋色狗艺术 | 热の无码综合 视频二区 | 国模私拍精品一区二区 | 国产系列久久影院 | 亚洲人成色7777在线观看不卡互動交流 | 欧美日韩国产经典一区 | 亚洲a∨好看av高清在线观看 | 亚洲国产高清精品影片 | 无码人妻一区二区三区密桃手机版 | 国产专区尤物极品在线 | 高潮喷水的毛片 | 2020精品国产黄片 | 天堂av网中文字幕 | 最新国内精品自在自线视频 | 国产96在线 欧美 | 亚洲精品日韩在线91 | 夜夜澡亚洲碰人人爱av | 国产成人午夜性Ä一级毛片 | 亚洲av无码一区二区在线 | a毛片免费全部播放无码视频大全 | 亚洲AV无码秘蜜桃八月未央 | 99草在线视频这里只有精品 | 图片区小说欧洲区 | 国产最黄最黄的裸片小视频免费看 | 欧美国产日本视频 | 日韩国产av二区 | 欧美人与动牲交ZOOZ3D | 99久久精品这里只有精品 | 青青国产精品最新网址 | 国产成人午夜高潮毛片刘涛 | 日韩欧美在线观看在线播放 | 一区二区三区午夜片 | 日韩欧美视频中文字幕乱码 | 久久精品中文字幕一区二区三区 | 国产亚洲精品网红 | 欧亚乱色熟女一区二区 | 国产黄色小视频在线观看 | 欧美婷婷六月丁香综合区 | 国产Ä一级无码毛片一区二区三区 | 日韩欧美中文字幕一区在线播放 | 国产av福利久久精品can二区 | 99热在线只有精品99 | 国产日韩一区二区免费 | 果冻传媒考研姐姐住我家 | 亚洲精品另拍偷拍 | 女生你别舔了啊的软件 | 日韩欧洲亚洲午夜久久久 | 午夜在线播放免费人成年 | 久久综合久久毛片 | 亚欧成人无码äV在线播放 | 精品一区二区免费视频 | 午夜末班车完整版在线观看 | 亚洲欧美日韩在线观看你懂的 | 美女乱子伦高潮在线观看完整片 | 99精品人妻专区在线视频 | 超碰国产精品9999久久久久 | 亚洲AV秘片一区二区三区 | 亞洲國產精品一區二區www' | 国产亚洲美女精品自在线拍 | 亚洲AV无码国产精品色午夜久久 | 青青爽国产手机视频播放 | 天天躁夜夜躁狠狠躁综合真实 | 亚洲午夜AAA片内谢无码理伦 | 亚洲深夜在线 | 網友分享久久精品无码一区二区三区心得 | h工口福利里番库全彩 | 日韩欧美视频中文字幕乱码 | 香蕉视频黄色下载 | 黄h欧美1区 2区 3区在线观看 | 精品亚洲免费久久 | 男女做A级毛片视频免费 | 国产00粉嫩馒头一线天91 | 中文字幕 日韩 欧美 最新 | 黄片污在线观看视频 | 国产乱淫片Av免费看 | 久久久噜噜噜久久熟中文 | 亚洲中文字幕无码一二三四区 | 97久久久久人妻精品一区 | 中文字幕亚洲手机在线视频 | 公交车上扒开嫩j挺进去视频 | 最近韩国日本免费观看MV | 精品国产一区二区三区无码乌克兰 | 日本乱辈乱奸视频中文字幕 | 91口爆吞精国产对白a在线观看 | 亚洲精品AⅤ无码精品丝袜无码 | 欧美怡红院视频一区二区三区 | 无码高清一区二区三区 | 久久中文字幕高清免费 | 很很在线视频观看 | 午夜在线观看中文字幕 | 成年女人a毛片免费视 | 又粗又硬又爽毛片免费放 | 三级视频欧美不卡在线观看 | 国内精品自线一区二区三区不卡 | 中中文字幕中文有码在线精品 | 亚洲av无码乱码在线观看看 | 亞洲綜合激情五月丁香六月 | 2020国产综合在线入口 | 午夜精品久久久久久毛片欲望 | 女网址www女高清中国 | 涩涩视频在线免费观看 | 男女18禁啪啪无遮挡免费视看 | 天天拍天天射人人 | 热综合一本伊人久久精品网址 | 国产啪啪啪啪啪啪电影观看 | 久久中文字幕网站深田咏美 | 精品中文字幕一区二区久久久 | 欧美激情免费在线观看 | 久久久久国产欧美久久久aaa | 国产特级毛片一级毛片国产 | 美日韩无码高清一区二区三区 | 韩国三级HD中文字幕三义 | 欧美精品欧美激情免费区 | 精品国产综合乱码久久久久久 | 国产精品一区二区三区色 | 精品国产sm全部网站 | 国产精品晓可耐在线观看 | 亚洲äv无码一区二区三区网站 | 欧美日韩永久久一区二区 | av网址大全性久久久 | 天天躁夜夜躁狠狠躁综合真实 | 好屌妞这里都是精品 | 日韩秋霞电影在线视频观看 | 中文字幕在线欧美日韩在线播放 | 99九九精品视频 | 成人Āv片无码免费天天看 | 日本天堂中文字幕有码 | 欧美日韩午夜高清无码一级片 | 日韩福利新一区二区 | 久久激情亚洲中文字幕国产精品 | 欧美综合中文乱伦 | 四川少妇搡BBB搡BBB爽爽爽小说 | 亚洲中文字幕久久久久综合 | 欧美日韩免费一区中文字幕 | 欧美视频一区二区三区高清不卡 | 冲田杏梨在线精品二区 | 国产又色又刺激高潮免费看 | 久久9精品国产亚洲av | 国产极品粉嫩馒头一线天图片 | 国产精品视频一区网址 | 四虎影视1515hh四虎免费 | 欧美黑人巨大精品一区二区 | 欧美 日韩 中文 国产 | 亚洲伊人tv综合网色 | 亚洲av无码精品色午夜在线观 | 亚洲精品中文字幕无乱码麻豆 | 亚洲AV无码鲁丝国产精品午夜站 | 久久久精品人妻无码专区不卡动漫 | 果冻传媒考研姐姐住我家 | 黄h欧美1区 2区 3区在线观看 | 伊人五月丁香综合aⅴ | 精品国偷自产一区2区三区久久 | 国产强奷在线播放 | 啦啦啦啦在线播放免费高清6 | 永久免费国产福利在线永久视频 | 四川老女人叫床視頻 | 日本国产免费亚洲 | 亚洲国产成人AⅤ毛片大全久久 | 91久久国产综合久久91精品网站 | 國產成人精品視頻在放 | 久久久亚洲欧洲日产国产成人 | 亚洲中文无码91成人丁香 | 午夜精区欧美一区二区 | 美日韩无码高清一区二区三区 | 9999热这里只有精品 | 日韩电影中文字幕在线观看 | 天天躁夜夜躁狠狠躁综合真实 | 男人把女人桶到爽免费看视频 | 国产一国产一本到免费 | 亚洲中文成人av一区二区 | 人妻激情无码在线 | 国产午夜亚洲精品理片不卡 | 久久大香香蕉国产免费网vrr | 人妻久久系列精品 | 亚洲伊人久久综合中文成人网 | 欧洲一级毛一级欧美 | 又大又粗黄片一二三级在线看 | 波多野结衣免费一区视频 | 强制黄色无码网址国产又大又粗 | 亚洲深夜在线 | 欧美片黄网站色大片 | 欧美亚洲综合精品区 | 久久一区二区三区精华液介绍 | 狠狠色噜噜狠狠狠狠米奇777 | 黄色天堂视频免费观看完整版高清国语自产精品 | 国产网红李雅福利在线 | 一级无 码在线观看 | 久久成人网视频 | 日本三级韩国三级韩级精品视频 | 欧美一级片内射视频在线播放 | 午夜精品久久久久99热 | 亚洲欧美国产日韩在线观看 | 小伙子和老妇videos | 全黄性性极高免费 | 免费看污的全亚洲网站 | 日韩人妻无码视频一区 | 一级aa午夜福利免费区 | 在线观看欧美精品免 | 最近2019中文字幕免费版视频5 | 综合人人97精品 | 亚洲一区二区三区不卡无码 | 日本夜爽爽一区二区三区等精彩节目 | 国产亚洲欧美日韩在线三区 | 上海艺校校花被猛艹在线观看 | 亚洲无码性爱视频网站 | 91大神娇喘女神疯狂在线 | 国产精品制服诱惑在线观看 | 免费看又黄又无码的网站草草久久久无码国产专区 | 暖暖无码视频一区二区无码免费 | 久久久久性色AV毛片特级 | 在线观看精品亚洲无码 | 幺女幺女国产一级中文毛片在线看 | 卡通动漫一区二区亚洲欧美 | 涩涩涩视频在线观看免费 | 看199级黄色毛片 | 免费黄色av中文大全 | 太粗太深了太紧太爽了动态图男男 | 亚洲精品97久久宅男 | 991久久久无码国产精精品免费 | 欧美中文字幕在线网址 | 精品丰满欧美一区二区三区 | 亚洲天天弄日日弄 | 最刺激的欧美三级中文字幕 | 全部免费毛片在线午夜裸体美女爆乳福利视频 | 看国产av毛片网 | 精品久久亚洲一区二区三区 | 最近2019中文字幕免费版视频5 | 91在线国产在线视频 | 幺女幺女国产一级中文毛片在线看 | 国产精品久久东京热好看到停不下来! | 天堂aw在线日韩动漫欧美 | 自慰少妇裸体无码30p | 久久久高校女厕所偷拍视频 | 日本在线播放五月天色五月 | 成年女人看片免费视频74 | 99国产精品毛片午夜电影网 | 看黄色三级片男人插女人逼视频 | 像素rpg黄油丧尸危机 | 欧美日韩国产一级久久忘忧草 | 亚洲国产综合精品中文第99 | 2020国产综合在线入口 | 深夜福利在线APP | 男人边吃奶边做边爱免费 | 欧美日韩一区二区三区aa | 中文字幕一区二区5566在线 | 国产精品三级av及在线观看 | 午夜激情在线播放 | 99呀re在线视频播放 | 国产会所嫖妓在线观看 | 欧美一级高清中文字幕视频 | 无码高清一区二区三区 | 美女自慰喷白浆网站 | 毛片男女啪啪内射无遮挡 | 人人91操操操人人人操操操 | 成人Ä毛片久久免费播放 | 无码äV综合网国产精品 | 亚洲v欧美v日韩v国产v | 国产精品视频一区二区首页 | 再把腿X开一点就可以吃扇贝 | 四虎影视1515hh四虎免费 | 97浪潮性色91久久久美川 | 国产免费大片a视频 | 亚洲无码视频大全在线看 | 国产会所嫖妓在线观看 | 黄色特级毛片高清免费 | 国产精品自产拍在线观看更新 | 中文精品日韩成人欧美 | 色欲久久国产色av免费看老司 | 狠狠色丁香婷婷久久 | 日本伦理在线观看中文字幕 | 在线观看欧美精品免 | 三级片中文网站日日爱 | 韩国三级中文字幕hd爽爽电影 | av久久久一区二区三区 | 女人被狂躁c到高潮喷水按 | 男人和女人一起打扑克牌app | 免费av网站大全久久 | 久久99视频免费 | 小宝寻宝2023在线观看免费 | 亚洲五月天台湾精品 | 亚洲欧美综合影视 | 全部免费黄色毛片 | 国产日韩欧美亚州精品中字95 | 污污草莓视频 | 国产午夜福利电影欧美日韩 | 最新国产三级在线观看不卡 | 在线国自偷图片亚洲 | 久久久成人影院 | 国内精品久久久久国产不卡 | 色精品人妻一区二区三区 | 日韩男男乱婬AAA高清视频 | 欧美性猛交xxxx乱大猛交3 | 国产精品一区二区免费在线观看 | 男女激情一级成人毛片免费看 | 欧洲亚洲成品在线播放av | 成人毛片一级在线播放 | 中文字幕亚洲综合久久2 | 欧美一极大片免费 | 成人午夜羞羞爽爽视频欧美 | 免费网禁呦萝资源网视频 | 亚洲欧美手机在线 | 亚洲一级特黄大片在线观看 | 国产精品国产精品国产精品 | 久久久手机版社区放荡免费 | 免费观看一级a愛视频网站 | 午夜亚洲AV永久无码精品麻豆 | 亚洲无码免费网站 | 日韩高清大片 | 精品国产欧美成在线观看 | 金发欧美一区在线观看 | 国产三级片一区二区精品在线观看 | 两个人免费完整直播 | 國內精品一區二區在線觀看 | 午夜免费精品久久久 | 精品久久久久蜜桃 | 国产免费综合色视频 | 日本免费AAA片一区二区三区 | 少妇性活BBBBBBBBB动漫 | 日本中文字幕一区在线 | 日韓激情小視頻 | 国产午夜精品91久久影院无码 | 亚洲精品午夜无码电影在线播放 | 中文字幕亚洲乱码精品 | 欧美国产成人精品一 | 久久96热在青草精品国产 | 又黄又粗色网视频 | 国产精品久久九九一区二区 | 中文字幕亚洲日韩在线2020 | 国语少妇高潮对白在线中文 | 午夜性a一级真人片 | 日本一道一区二区美利坚欧美 | 人妻少婦精品視頻一區二區三區 | 亚洲欧美综合茄子 | 91久久精品国产亚洲ą∨麻豆 | 亚洲女性午夜在线视频 | 久久久手机版社区放荡免费 | 亚洲欧美日韩国产精品第不页 | 国产美女精品免费在线观看 | 国内最新91在线视频 | 国产精品一二区三区 | 天天射狠狠的操互動交流 | 24小时国产综合成人久久大片91 | 国产免费特级高清 | 美女隐私秘视频黄www曰本 | 一级做a爰片性色毛片成人久久久国产一级a毛 | 久久9精品国产亚洲av | 久热传媒在线免费观看视频 | 草莓视频www在线播放 | 中文字幕无码综合第二页 | 国产男女猛烈无遮挡免费观看网站 | 午夜视频在线观看一区二区福利 | 亚洲成人一级日韩精品麻豆 | 国产惠奈酱视频在线播放 | 香蕉网久久综合影院 | 欧洲日本亚洲一区二区 | 日韩成人免费在线视频 | 亚洲国产日产韩国欧美综合 | 国产少妇国语对白污 | 欧美国产一级特黄AAA大片在线观看 | 亚洲伊人精品综合在合线 | 在线国产视频一级片哪里看 | 欧美国产日本视频 | 欧美一区精品亚洲日韩 | 中文字幕亂碼中文亂碼51精品 | 欧美精品一区二区大全 | 人妻丰满熟妇av无码区色老汉 | 久久九九999视频免费 | 亚洲精品国产AⅤ综合第一己 | 国产福利午夜自产拍视频在线 | 噜噜噜久久久 | 欧洲日韩一区二区 | 欧美日韩免费一区二区在线观看 | 网站有海量精选视频→日韩日韩日韩日韩精品 | 色婷婷五月六月综合激情 | 黄h欧美1区 2区 3区在线观看 | 3atv国产精品视频 | 99久久精品这里只有精品 | 97人人超碰国产精品最新o | 乱子仑免费视频一区二区 | 免费无码一区二区三区A片百度 | 精品国产性色无码A v网站 | 亚洲人成手机电影网站 | 亚洲春色中文字幕久久久 | 高潮国产喷水白浆久久 | 特级毛片s级全部免费 | 亚洲综合中文精品 | 亚洲综合日韩a无码毛片 | 久久久亚洲精品好片 | 加勒比av高清无码下载 | 海量成人精品国产av | 国产在线看片网站 | 五月丁香亚洲综合在线 | 亚洲啪AV永久无码精品放毛 | 亚洲精品午夜无码电影在线播放 | 上海艺校校花被猛艹在线观看 | a级毛片无码免费观看 | 欧美一区二区三区高清视频 | 久久久精品影院妓女 | 日韩精品三级一区二区三区 | 日韩中文字幕免费无码视频 | 婷婷国产高清视频 | 国产无遮挡又粗又又猛又爽 | 日本一区二区三区日本视频 | 午夜理论日本乱人伦片中文 | 日本中文免费一区二区 | 国产爆乳福利在线观看 | 欧美亚洲另类精品精品一区 | 国产精品午夜福利小视频合集 | 中文字幕+媚药+日韩精品 | 日韩a∨无码一区二区三区不卡 | 日韩熟妇啪啪无码视频 | 私人vps一夜爽毛片免费 | 最近2019中文字幕免费版视频5 | 少妇性活BBBBBBBBB动漫 | 欧美视频一区高清不卡 | 欧美三级在线观看中文 | 四虎影视1515hh四虎免费 | 亚洲r成人av久久人人爽 | 亚洲乱亚洲乱妇22p | 中文字幕亚洲一区二区乱码熟女 | 粉嫩av国内精品人人爽 | 日韩免费毛片黄片 | 久久秋霞电影亚洲国产精品 | 亚洲成人国产资源 | 国产97超碰人人做人人爱 | 欧美一区二区三区高清视频 | 久久爰XXXⅩ高潮喷水 | 双飞两女视频一区二区 | 免費無碼成人AV在線播 | 欧美在线换91视 | 亚洲熟女乱色一区二区三区麻豆 | 国产精品视频一区国模私拍丝袜 | 伊人精品无码精品网站 | 尤物国产在线精品福利三区 | 美女自慰在线观看 | 久久精品欧美一区二区三区麻豆 | 久热这里只有精品视频在线 | 在线 亚洲 校园 在线 无码 | 男女激情一级成人毛片免费看 | 中文自拍无码精品 | av不卡网久久久久久久久久 | 欧美特黄三级XXX在线观看 | 东京无码久久精品 | 亚洲成av动漫人片在线观看无码 | 欧美日韩国产精品性行为 | 超碰caopor国产公开 | 中文字幕韩国三级少妇在线光看 | 最新亚洲中文字幕无码在线 | 桃红色世界最快永久2023 | 乱码国产丰满人妻www69 | 国产精品人妻久久毛片一 | 午夜污色无遮挡在线观看 | 亚洲无码之亚洲性爱 | 色欲色欲日韩www在线观看 | 国产在线观看人成激情视频 | 亚洲东京热无码素人久久久 | 国产免费三级在线观看网站 | 一级作爱免费视频在线 | 亚洲国产一区二区a毛片变态 | 日韩一区二区三区午夜免费视频 | 亚洲午夜AAA片内谢无码理伦 | 麻豆一卡2卡三卡4卡网站在线 | 日韩毛片视频免费在线播放 | 美女被到高潮喷出白浆www | 欧美久久久人妻 | 久久刺激cijilu福利一区 | 野花香日本电影高清免费观看7 | 日韩专区亚洲综合久久 | 成人妇女免费播放久久久午夜射精日本三级 | 84PAO国产成视频免费播放 | av高清免费在线观看 | 欧美A级毛片免费播敢 | 国产v亚洲v欧美v专区 | 精品蜜臀久久久久97网站 | 夜夜高潮夜夜爽高清视频 | 亚洲精品少妇娇喘 | 日韩在线不卡视频免费 | 亚洲精品高清毛片 | 男生操女生的应用 | 91亚瑟成人久久91精品 | 你懂得2019在线观看网站 | 亚洲av无一区二区三 | x8x8国产在线最新地址 | 亚洲日本黄色免费观看 | 亚州无码av一区二区 | 精品国产一区二区三区久久久蜜臂 | 五月丁香亚洲综合在线 | 高清无码精品综合一区二区三区色片 | 最新欧美精品一区二区视频 | 综合婷婷欧美日本韩国一区 | 91精品国产一区二区三区免费 | 99久久精品少妇高潮喷水 | 成全视频在线观看免费播放 | 国产精品九九九无码喷水 | 超碰国产精品9999久久久久 | 欧美特黄三级XXX在线观看 | 欧美猛男的大粗鳮巴视频 | 一级毛片视频国产 | 国产户外调教视在线播放 | 寂寞少妇挑战18厘米黑人 | 色综合综合色欧美一区 | 1024cc香蕉视频成人免费 | 亚州一区二区三区a级片免费观看 | 今天高清视频免费播放中国 | 97精品国产97久久久久久免费 | 农村妇女一级毛片久久 | 韩国亚洲精品A在线无码 | 国产啊v在线看免费播放 | 欧美黑人巨大日本人又爽又色 | 国产麻豆剧传媒精品国产剧 | 亚洲日韩中文字幕无码強姦 | 精品国产av无码一区二区 | 久久精品亚洲人成 | 天海翼无码天堂一区二区三区 | 四川少妇搡BBB搡BBB爽爽爽小说 | 国产高清吃奶成免费视频网站 | 海量成人精品国产av | 国产一级黄色片免费播放 | 国产专区一线二线三线码 | 国产操逼色网视频 | 偷自拍亚洲欧美一区二页 | 成人国产综合av | 国产日本高清一区 | 一区二区三区免费视频不卡 | 久久天天躁狠狠躁夜夜äv浪潮 | 日本最大色倩网站www不卡 | 久久精品国产亚洲ąV无码麻豆 | xxx视频在线观看 | 日韩中文高清字幕 久久 | 大胸校花被老头粗暴在线观看 | 国产欧美日97久久久久国产精品嫩草影院 | 欧美三级福利片 | 国产亚洲高清在线精品99 | 成年女人看片免费视频74 | 天天影视久久综合综合久久 | 婷婷久久人人爽人人爽 | 五月丁香亚洲综合在线 | 天堂aw在线日韩动漫欧美 | 真人一级毛片国产 | 制服丝袜三级片激情综合色 | 中文精品在线观看综合 | 91av国产在线91精品熟妇 | 欧美另类偷自拍情纯唯美 | 日本WWW色欧美美女性爱视频 | 国产亚洲成av人在线观看导航 | 亚洲AV成人无码网在线看 | 视频一区二区村上凉子 | 少妇又紧又爽又黄的视频 | 日本在线高清不卡一区二区 | 北条麻妃大战黑人在线观看 | 国产69麻豆精品无码一区 | 国产在线播放一区二区三区国产在线播放 | 一区二区三区色欲av性爱 | 中文字幕在线一级黄片 | 国产亚洲美女精品自在线拍 | 免费看特黄色一级片 | 蜜桃传媒秘色网视频网站 | 亚洲第无码av无码专区 | 国产国语久久91老女人 | 麻豆av巨作在线观看 | 成人免费毛片毛片 | 亚洲综合在线一区高清在线观看 | 2018天天躁夜夜躁狠狠躁ap | 日韩成人一区二区三区在线观看 | 日韩大片免费在线观看 | 成人精品电影一区二区三区 | 少妇被粗大的猛烈进出69影院 | 国内精品免费视频一二 | 久久国产精品99国产精2021 | 毛片视频2022免费看 | 三级国产国语三级在线 | 欧美黄色性爱视频 | 亚洲中文无码91成人丁香 | 精品国产欧美成在线观看 | 五月丁香亚洲综合在线 | 久久99国产麻豆一区二区三区网站 | 国产av电影一区二区三区 | 国产欧美日韩vā另类在线播放 | 夏目彩春猛烈肉体破坏版 | 亚洲囯产另类久久久精 | 狼友av在线播放 | 亚洲日本vÄ中文字幕久久 | 亚洲熟妇无码av在 | 日韩欧美国产高中不卡在线观看 | 午夜理论日本乱人伦片中文 | 久久精品亚洲中东京热 | mav影视视频网站 | 国产乱子伦精品免费无码专区 | 久久精品欧美一区二区三区麻豆 | 亚洲国产日韩a在线播放性色 | 中文字幕亚洲伊人一区二区三区 | 按在阳台上疯狂的进入 | 成人av久久一区二区三区 | 91av国产在线91精品熟妇 | 欧美精品特黄A片色欲AⅤWWW | 国精一二三区别免费观看 | 国产а天堂在线 | 日韩少妇人妻无码精品网 | 又黄又粗色网视频 | 亚洲影视av一区二区三区在线观看 | 少妇大胆瓣开下部自慰 | 国精品无码一区二区三区在线蜜 | 日韩精品中文无线码 | 午夜在线免费观看小视频 | 激情av女国产剧情对白 | 欧美亚洲动漫国产日韩久久99 | 久久亚洲中文字幕精品一区二 | 女女互磨豆腐高潮喷水AV | 日韩福利国内主播在线播放网站 | 成人av久久一区二区三区 | 国产精品视频免费观看2024 | 偷拍亚洲欧美日韩一区二区 | 天天躁夜夜躁狠狠躁综合真实 | 亚洲精品国产污污在线观看 | 亚洲精品日韩中文字幕在线 | 人妻碰碰人妻碰碰 | 欧美视频在线播放一区二区 | 日本高清毛片免费视频 | 99久久精品国产一区二区 | 超级yin荡的人妇 | 亚洲视频小说之无码 | 一级aa午夜福利免费区 | 好深好湿好硬顶到了好爽H动态图 | 亚洲日韩国产一区二区色欲 | 日本夜爽爽一区二区三区等精彩节目 | 東北婦女精品BBWBBW | 一本大道heyzo无码专区 | 无遮羞肉体动漫影院免费版 | 国产一区免费精品视频 | 国产无码乱辈伦在线播放视频 | 女王调教免费专区视频 | 99久久精品这里只有精品 | 一级特黄牲大片免费视频 | 亚洲国产综合精品中文第99 | 国产主播久久精品一区二区三区 | 国产一区二区人妻白浆屁股撅起来 | 99热这就是精品国产 | 日韩看片自拍视频在线观看网站 | 美女裸照无遮挡18禁国产 | 69久69久久高清一区二区三区 | 国产免费毛不卡片 | 日韩a∨无码一区二区三区不卡 | 日韩三级理论 | 日韩和亚洲的日本品牌区分 | 亚洲人成色7777在线观看不卡互動交流 | 日韩秋霞电影在线视频观看 | 99久久國產熱無碼精品免費 | 亚洲AV永久天码精品天堂 | 国产免费三级在线观看网站 | 黄片污在线观看视频 | 欧美日韩免费观看视频 | 国产精品第1页在线播放 | 亚洲日本vÄ中文字幕久久 | 免费观看的黄片 | 国产又大又黄又粗又长的视频 | 日韩AV无码每日更新 | 色哟哟视频在线观看免费播放 | 日日噜噜噜夜夜爽爽狠狠69 | 福利精品国产自产在线 | 日批视频在线免费观看 | 国产白丝精品爽爽久久久久久蜜臀 | 欧美特黄一级大片999 | 亚洲国产精品一区二区成人小说 | 国产视频一区视频二区 | 一级aa午夜福利免费区 | 国产极品精品婷婷久久精品 | 国产精彩视频在线观看91 | 真实偷拍厕所尿尿视频 | 免费免费国产在线观看 | 天堂五月av进入 | 久久精品人妻一区二区三区av | 色四月婷婷网五月天在线观看 | 大屁股美女一级毛片 | 亚洲综合精品日韩欧美在线一区 | 99视频精品免费视频 | 国产福利午夜自产拍视频在线 | 亞洲六月丁香繳情久久丫 | 日本羞羞黄A视频在线观看 | 69精品久久久久久久久久久国产 | 国产精品视频一区网址 | 操逼无码视频 | 国产亚洲色婷婷91久久99精品91 | 黄www羞羞视频在线观看 | 欧美性爱高清视频在线免费 | 国产真人一级片一级特黄高清aaaa大片 | 国产精品国产亚洲区久久 | 无码国产āV精品一区二区 | 污污小视频全免费软件 | 在线观看片免费人成视频无码 | 伊人网一本三区五月婷婷伊人久 | 国产情品欧美一区二区三区精品 | 国产av亚洲精品久久久久 | 日韩av免费精品一区二区国产 | 最近最新中文字幕大全手机在线 | 日韩黄色毛片一级 | 女人在厨房被添高潮全过程A片 | 十八禁羞羞视频爽爽爽 | 亚洲AV成人无码网在线看 | 伊人五香丁香婷婷天堂网 | 国产一级毛片无码视频越南 | 久久刺激cijilu福利一区 | av午夜精品在线观看 | 亚洲国产成人国产尤物在线播放 | 欧美a一级特黄大片 | 5566先锋资源在线观看 | chinese实践打屁股视频网站 | 日韩欧美在线观看在线播放 | 亚洲中文字幕久久久久综合 | 美女视频黄不卡免费无遮挡 | 24小时更新在线观看片 | 久久精品永久免费看 | 久久久久亚洲精品网站 | 高清午夜福利电影在线 | 国产成+人+综合+欧美 亚洲 | 久久国产亚洲精选AV | 视频成人app永久免费看片 | 2021亚洲а∨天堂在线 | 五月丁香久久亚洲欧洲日本 | 国产成人亚洲影院在线 | 欧美激情欧美精品色欲少妇 | 北条麻妃大战黑人在线观看 | 无码不卡中文字幕在线视频20 | 免费亚洲永久一区二区三区 | 全部免费毛片在线午夜裸体美女爆乳福利视频 | 国产亚洲精品网红 | 免费va欧美在线观看 | 婷婷精品久久免费视频 | 久久99视频免费 | 亚洲国产日韩欧美精品 | 鲁大师欧美情涩网5566 | 亚洲AV成人无码网站18禁网址 | 一本色道无码AV竹菊影视 | 日本不无在线一区二区三区 | 免费看污的全亚洲网站 | 给我看免费播放的片在线观看 | 亚洲区自拍偷拍视频 | 野花日本高清免费6 | 国产精品一区二区免费在线观看 | 欧美一级a爱片免费观看看 | av日韩在线播放中文字幕 | 久久久精品网站无码 | 午夜小视频在线观看欧美日韩手机在线 | 加勒比av高清无码下载 | 亚洲自偷自偷制服丝袜图片 | av女优在线一区二区 | 久久久久精品免费播放 | 99re6免费视频 这里只有精品 | 色老板成人永久免费视频 | 亚洲日韩中文字幕一区第一页 | 欧洲视频中文字幕在线播放 | 亚洲成av人片在线播放一区二区 | 又大又粗黄片一二三级在线看 | 免费观看亚洲精品国产成人99久久 | 国产视频搜索在线直播 | 国产精品六区久久综合亚洲 | 69堂精品视频在线观看 | 色婷婷视频在线播放 | 亚洲区日韩区主播传媒 | 先锋亚洲国产的黄片 | 午夜国产成人福利片在线观看 | 欧美特黄三级XXX在线观看 | 无码少妇视频一区二区三区 | 伊人久久大香线蕉无码不卡亚洲 | 亚洲a√色网视频 | 日韩欧美午夜精品91久久久 | 久久国产香蕉精品一区二区三 | 偷拍亚洲欧美日韩一区二区 | 精品人妻系列人妻系列2020 | 不需要付费的污软件 | 无码av免费一区二区三区 | 国产成人无码午夜大片 | 把我绑在床头虐奶头 | 久久久久亚洲精品网站 | 亚洲性爱无码在线免费观看 | 亚洲黄色成人在线看精品 | 妺妺的荫蒂让我添高潮了视频 | 成人區人妻精品一區二區不卡視頻 | 亚洲伊人tv综合网色 | 原创国产第一页AV日韩高清在线 | 亚洲人看A∨免费片 | 99热这就是精品国产 | 香蕉国产一区视频 | 午夜大片欧美在线 | 殴美国产中文字幕视频在线观看 | 挡不住的风情在线观看 | 羞羞午夜日韩AV电影 | 在线观看一区二区欧美日韩 | 日韩欧美视频免费在线观看 | 精品人妻系列人妻系列2020 | 欧美精品乱子乱一区二区三区 | 亚洲AV无码秘蜜桃八月未央 | 无码少妇免费一区二区三区 | 国产另类精品久久久久 | 人妻无码一区二区三区不卡 | 在线看h片z在线看 | 亚洲v欧美v日韩v国产v | 免费看片在线网站 | 不卡无码在一区二区三区四区 | 8090成人午夜精品 | 色在线视频免费观看视频 | 国产精品久久香蕉免费播放 | 喜爱夜蒲2卫生间做爰 | 国产av电影免费体验播放入口 | 中文字幕综合淫色人妻美女视频电影 | 国产精品99久久久精品三级无码 | 综合人人97精品 | 久久午夜夜伦鲁鲁片无码免费播放区 | 日本熟妇久久久久久一区二区 | 国产人成午夜免免费观看 | 亚洲中文字幕久久久久综合 | 嗯~乖自己摇H尿出来 | 无码中文人妻精品2020 | 波多野结衣少妇人妻内射 | 操美女逼黄片视频 | 三级综合精品欧美 | 日韩欧美中文久久按摩视频 | 国产真人一级片一级特黄高清aaaa大片 | 97久久久亚洲综合久久 | 草b视频在线观看 | 久久成人αv国产精品一区区 | 草莓色视频在线观看 | 女人18毛片毛片毛片毛片区二 | 无码人妻精品区二区蜜桃91 | 久久国产精选AV免费 | 欧美日本视频一区 | 中文久久精品无码 | 久久久精品国产亚洲Äv日韩 | 中文字幕在线男人的天堂 | 国产在线播放精品视频 | 惠民福利国产精品毛片一区二区 | 国产精品无码综合网 | 台湾午夜a级理论片在线播放 | 日本人69视频页码13 | 精品丰满一区二区三区 | 亚洲国产欧美在线看片一国产 | 老色69久久九九精品高潮 | 97热久久免费视频 | 欧美欧美二区毛大片 | 国产精品久久首页 | 我和亲妺作爱妺妺下面好湿 | 手机影视久最新av | 国产精品久久久久久免费播放等最新内容! | 欧美亚洲综合二区 | 国产一级αα无码大片 | 放荡的三级护士国产精品主播 | 国产xxxx视频免费播放 | 亚洲av成人片色在线观看蜜桃 | 国产极品精品婷婷久久精品 | 欧洲 日韩中文无码视频 | 国产精品无码一区二区三区在线看 | 精品一卡2卡3卡4卡新区在线 | 久久精品免费黄色一级大片 | 男进女内免费视频无遮挡 | 欧美视频一区高清不卡 | 日韩三级理论 | 亚洲综合中文精品 | 黑人巨大精品欧美视色 | 国产高清无码网站 | 亚洲一级av不卡毛片无码 | 国产在线观看免费观看不卡 | 在线日韩中文字幕视频 | 久久午夜夜伦鲁鲁片无码免费播放区 | 久久影院国产精品 | 尤物午夜视频日韩免费播放 | 免费一级a毛片在线视频播放 | 亚洲精品成人无码毛片 | 精品人妻无码一区二区suv免费AV | 400部精品国偷自产在线 | 成人黄色毛片一级片 | 久久精品国产亚洲av麻豆图片 | 欧亚1区2区3区视频 | 国产一区二区yy精品无码毛片 | 国产91久久精品成人看 | 看免费国产日屄片 | 一级肉体全黄裸体片 | 99re6免费视频 这里只有精品 | 亚洲国产日产韩国欧美综合 | 亚洲国产精品网站大全 | 51成人免费影院 | 国产又粗又猛的视频 | 日本无码人妻熟妇人妻av | 全部免费毛片在线午夜裸体美女爆乳福利视频 | 69精品久久久久久久久久久国产 | 国产精品成人短视频 | 色呦呦免费在线观看 | 日韩在线开心五月 | AV女优视觉盛宴在线 | 国产毛片在线一区 | 国产精品亚洲精品久久国语 | 亚洲免费精品网站 | 国产精品人妻系列21p | 99久久婷婷国产综合精品hsex | 永久免费av片在线观看全网站 | 草民网限制A级福利片 | 自拍高清在线观看中文 | 亚州Av片在线劲爆看 | 日韩在线视精品在亚洲 | 亚洲成人午夜福利网站 | 无码毛片在线 | 国产成人无码午夜大片 | 欧美日韩免费一区二区在线观看 | 97在线观看全部视频 | 国久久婷婷国产综合精品 | 8X国产精品一区 | AV高清毛片免费 | 国产美女一级做a爱视频 | 色噜噜伊人久久精品 | 六月丁香婷婷激情国产 | 911国产爱豆剧传媒在线观看 | 饥渴老熟妇乱子在线播放 | 国产zw在线一区 | 高清不卡免费直播毛片 | 久久亚洲中文字幕精品一区二 | 国内精品自线一区二区三区不卡 | 高清亞洲歐美在線看 | 国产无码123在线观看 | 欧美日韩精品一级高清 | 国产浴室偷窥在线播放 | DVD原版蓝光版中文字幕包 | 亚洲区成人久久九 | 乱码国产丰满人妻www69 | 亚洲精品乱码久久久久久自慰国产卡一卡二无线乱码 | 超碰成人免费观看在线 | 一丝不遮视频免费观看 | 色欲色欲日韩www在线观看 | 黄色一级片毛片 | 亚洲日韩亚洲另类激情文学 | 成人妇女免费播放久久久午夜射精日本三级 | 国产三级电影精品在线 | 久久99国产精品果冻大片 | 国产ąⅤ精品一区二区三区 | 国产免费免费人成视频网址 | 欧美大片欧美激情性色a∨在线 | 日韩欧美一级a不卡 | 天天射狠狠的操互動交流 | 日韩一区二区三区四区五区 | 精东影业jdmy国产 | 乱人伦视频中文字幕预告片 | 国产成人久久综合777777麻豆 | 俄罗斯精品18videosex性 | 国产无码乱辈伦在线播放视频 | 尤物视频一区 | 国产一区美女看片 | 日韩一级色网中文字幕 | 色妞综合视频一区 | 善良搜子的高潮中字在线观看 | 天天免费看国产www | 精品国产一区二区三区AV麻久久久久 | 在线亚洲精品国产成人二区 | 97在线观看全部视频 | 男人天堂久久 | 亚洲欧美日韩中文视频久久 | 小早川怜子在线视频欧美激情 | 小h片资源免费观看在线 | av女优网站一区二区 | 国产视频尤物精品一区 | 男女国产精品久久久 | japanesexxxx日本熟妇伦视频 | 美女扒尿口让男人桶动态图 | 国产toupai亚洲精品 | 久久天天躁夜夜躁狠狠躁综合 | 国产成人AⅤ免费视频 | 第一区不在线视频 | ◐愛妃視頻◑国产精品99无码一区二区 | 国产精品午夜福利电影 | 少妇大胆瓣开下部自慰 | 亚洲欧美日韩国产精品第不页 | 亚洲a网一区二区 | 亚州人成人77777网站 | 久久精品中文字幕第一页 | 欧美一级www内射 | 日韩一级精品视频在线观看视频 | 日产一区二区三区精品视频在线 | 亚洲国产成人精品女久久久 | 亚洲有码在线视频 | 无码不卡中文字幕在线视频20 | 连续热门一级国产a毛精品高清画质亚洲AV最新4K播放 | 26uuu国产在线精品一区二区 | 欧美亚洲日本国产丁香五月天 | 深夜男女啪啪羞羞无遮挡网站 | 100部乱大合集小说 | 欧美日韩在线视频看看 | 欧美日韩国产一级久久忘忧草 | 少妇高潮一区二区三区99欧美 | 日本精品中文字幕一区二区三区 | 日韩精品一九区熟女中文字幕 | 激情无码专区在线观看 | 精品国产依人香蕉在线精品 | 亚洲欧洲清纯在线 | 91麻豆精品國產自產在線觀看一區 | 趁着朋友出差受不了正在播放 | 大肉大捧一进一出视频不忠 | 初高中生洗澡福利视频网站 | 国产午夜激无码av毛片不卡 | 少妇被粗大的猛烈进出69影院 | 日韩人妻无码视频一区 | 亚洲精品国产av成拍成拍 | 老板含着她的花蒂啃咬高潮的视频 | 午夜小视频在线观看欧美日韩手机在线 | 亚洲国产精品成人久久久99免费无码 | 国产欧美vÄ欧美vÄ香蕉在线 | 成全视频在线观看免费高清版有多少集? | av片成人无码免费观看 | 久久亚洲欧美视频1025 | 亚洲欧美V一区二区 | 中文与幕中文字幕在线中二区 | 国产亚洲成av人在线观看导航 | 国产婷婷久久婷婷 | 亚洲人妻日韩欧洲中文字幕 | 制服丝袜亚洲中文在线观看 | 特级西西4444WWW无码 | 国产又刺激又黄又免费的视频 | 成人福利在线免费观看 | 国产精品 十八爽爽爽 | 国产性爱精品家庭乱伦视频免费观看 | 精品精品国产av | 24小时国产综合成人久久大片91 | 思思久久96热在精品国产精品 | 韩漫无遮挡免费网站 | 婷婷一区二区三区综合 | 欧美中文日韩亚洲 | 亚洲超清无码中文字幕 | 精品视频人妻少妇一区二区三区 | 久久夜色精品国产AⅤ无码 | 色欲久久国产色av免费看老司 | 亚洲av秘 精品久久不卡 | 亚洲不卡中文无码 | 亚洲日韩另类综合色图 | 狼色精品人妻在线视频 | 91在线精品欧美在线 | 精品国产污污污污污网站 | 久久中文字幕高清免费 | 亚洲国产日韩欧美综合久久 | 24小时国产综合成人久久大片91 | 国产成人av在线播放电影 | 97浪潮性色91久久久美川 | 国产欧精品一区久久久久久 | 18禁无遮挡啪啪无码网站 | 美女美女丝袜视频一区二区三区 | 国产永久免费高清在线观看视 | 免337p日本欧洲亚洲大胆色噜噜 | 亚洲av乱码国产 | 麻豆精品一级黄片在线 | 婷婷五月天黄色视频 | 精品一区二区三区在线观看婷婷 | 国产zw在线一区 | 人人澡人人爽 | 精品国产美女直播在线观看 | 国产特黄观看视频 | 国产青青视频在线观看99 | 福利国产片永久免费AV | 国产三级电影精品在线 | 精品国产最大网站麻豆 | 成人做爰免费视频免费看 | 四虎免费最新在线永久4HU | 精品综合免费国产中文无码影视 | 刘玥和闺蜜99部精彩视频国产 | 亚洲影视一区 | 亚洲第一页黄 | 国产精品一级a级理论片在线观看 | 色二区资源在线视频 | 国产精品一区无码中文字幕 | 国产日韩欧美丝袜一区二区 | 国产在线拍揄自揄拍有码 | 日韩欧美在线视频一区二区三区 | 超虎粉嫩自慰观看 | 窝窝午夜论理日本片 | 日韩精品一区二区三区在 | 欧美一级日韩级黄色片 | 久久草草综合精品导航 | 新建文件夹2韩版韩国完整 | 亚洲国产欧美另类刺激在线 | 午夜爽爽性刺激一区二区视频av | 国产精彩视频在线观看91 | 国产精品成人无码a片免费看 | 亚洲免费a级黄片 | 久久久亚洲欧洲av | 最新無碼專區視頻在線 | 日韩在线精品人妻中文字幕 | 欧美中文字幕在线网址 | 免费一区亚洲热香蕉有码 | 亚洲日韩欧美黑丝免费播放 | 一级a做一级a做片性视频 | 国产精品黄p在线免费观看 | 女人18毛片毛片毛片毛片区二 | 1024手机看片你懂的免费 | 日韩无码中字一二三区 | 精品国产一区二区三区在线电影 | 草莓视频APP污下载安装 | 午夜精品АⅤ天堂中文在线 | 国产精品扒开腿做爽爽的软件 | 午夜性色福利视频久久 | 亚洲一区亚洲二区国产 | 91传媒制片厂app官方网址 | 久久综合结合久久国产免费 | 久久九九无码A√视频 | 午夜在线播放免费人成年 | 国产激情久久老熟女精品视频 | 91口爆吞精国产对白a在线观看 | 老子影院在线观看理论片四虎 | jiZZ成熟丰满女人少妇直播 | 亚洲VA欧美VA人人爽变性人 | 中文字幕综合久久久久 | japanese日本熟妇多毛 | 亚洲a∨高清激情一区成熟一级毛片 | 欧美国产日韩欧美在线视视频 | 波霸爆乳一区二区国产 | 亚洲黄色av一区 | 国产高清精品自在线看 | 一卡二卡在线观看日本成人 | 性综合欧美另类 | 国产精品六区久久综合亚洲 | 亚洲性爱无码在线免费观看 | 夜夜揉揉日日人人视频 | 久久亚洲a∨无码精品色午夜麻豆 | 看日逼的软件 | 丰满大屁股熟妇猛交xxoo | 日韩精品亚洲麻豆一区二区 | 免费AA级毛片av无码无广告 | 久草福利资源在线观看 | 一区二区三区免费在线视频。 | 打扑克牌又疼又叫直播软件 | 绝伦老人公肉翻波多野结衣3 | 大粗鸡巴久久久久久久久 | 性生交大片免費看女人按摩 | 精品无码人妻一区二区免费16 | 口爆精饮系列大合集在线 | 在线播放连续内射爽翻天vol | 老师在上课时露出奶头 | 欧洲av免费看青草社区在线观看 | 日韩女邻居丰满的奶水在线 | 91亚洲精品尤物视频 | 日韩制服丝袜无码av | 最近韩国日本免费观看MV | 无码aⅴ无码天堂资源网z | 免费一级片二区三区 | 久久精品欧洲AV无码四区 | 久久精品中文字幕一区二区三区 | 久久精品欧美一区二区三区麻豆 | 国产一区美女看片 | 亚洲成人av美女精品在线 | 麻豆av巨作在线观看 | 亚洲91精品网站无码 | 日韩福利国内主播在线播放网站 | 中文字字幕在线精品乱码高清 | 久久青青草原精品国 | 国产一级αα无码大片 | 一级片内射欧美一区二区 | 成人无码网站在线免费观看 | 中文字幕国产在线播放黄色 | japanesexxxx日本熟妇伦视频 | 亚洲av成人一区二区三区观看在线 | 亚洲成人av一二区 | 精品无码人妻一区二区免费16 | 在线观看高清黄网站免费视频 | 国产精品一区二区av麻豆小说 | chinese实践打屁股视频网站 | 亚洲精品精华液一区二区天堂8 | 波多野结衣中字乱码 | 久久91这里国产精品 | 日韩一级无码av电影 | 午夜小电影国产在线播放 | 国产麻豆剧传媒精品国产剧 | 野花社区一本自拍乱拍 | 久久99九九99九九精品 | 国产欧美一区二区免费播放视频 | 国产亚洲精品aa片在线爽 | 日本福利片秋霞国产午夜 | 欧美精品一区日韩专区 | 啵多野结衣无码在线观看 | 午夜福利APPAV女优 | 欧美亚洲另类精品精品一区 | 亚洲乱亚洲乱妇22p | 精品无码一区二区免费视频 | 亚洲一卡二卡三卡四卡无卡网站 | 91秦先生久久久久久久 | 亚洲AV综合色区无码三区偷拍 | 色婷婷五月六月综合激情 | 久久天天躁夜夜躁狠狠躁综合 | 亚洲午夜精品久久久久久APP国产欧美日韩免费看AⅤ视频 | 84PAO国产成视频免费播放 | 精品综合免费国产中文无码影视 | 男人猛烈进入女人下部视频 | 99热久久视频只有精品在线 | av久久久一区二区三区 | 国产高清欧美在线2022 | 午夜欧美一区二区三免费观看 | 在线观看欧美精品免 | 3D动漫无码AV禁在线无码 | 日本三级韩国三级韩级精品视频 | 亚洲综合精品日韩欧美在线一区 | 国内精品宾馆在线精品酒店 | 成人區人妻精品一區二區不卡視頻 | 中文字幕影音先锋二十八页 | 粉嫩虎白女在线观看中国女 | 国内精品久久人妻无码hd毛片 | 纤纤影视视频二熟女 | 亚洲高清AV无码免费在线观看 | 日韩女邻居丰满的奶水在线 | 久久精品中文字幕第一页 | 苍井空无码av丁香五月 | 少妇精品视频无码深喉 | 欧美性猛交xxxx乱大猛交3 | 香蕉视频在线观看入口 | 国产一区美女看片 | 亚洲日本黄色免费观看 | 黄在线观看在线播放720p | 久久精品99狠狠色 | 亚洲AV无码鲁丝国产精品午夜站 | 超虎粉嫩自慰观看 | 人妻丰满熟妇av无码区色老汉 | 国产91精品一区二区色情男男 | 小雪被老汉各种姿势玩 | 久久六免费视频免费观看 | 国产午夜福利播放 | 久久一区二区三区精华液介绍 | 国产十八禁午夜电影在线观看 | 欧美成人一区在线 | 精品一区二区三区亚洲A∨ | 可以做羞羞事的模拟器下载 | 极品国模无码国产在线观看 | 真人毛片一级播放视频 | 26uuu久久五月天 | av中文字幕精品一区二区久久久 | XX性欧美肥妇精品久久久久久 | 妺妺的荫蒂让我添高潮了视频 | avAV一区二区三区在线 | 无码人妻专区AV一区二区 | h肉动漫无码无修6080动漫网 | 人妻无码中文激情在线不卡 | 国产精品一区二区av麻豆小说 | 神马影院线手机理论午夜 | 天天躁狠狠躁夜躁2 | 免费一区亚洲热香蕉有码 | 中文亚洲欧美乱码在线观看資源免費看 | 天天看天天爽天天摸天天添 | 国产高潮视频 | 亚洲大片高清在线播放 | 高清午夜福利电影在线 | 亚洲欧美手机在线 | 亚洲无码免费网站 | 1024看片欧美xxapp高清 | 日本夜爽爽一區二區三區 | 久久91亚洲精品久久91综合 | 国产熟女高潮视频 | 爽爽无码18禁免费国产 | 黄色小视频在线观看网站 | 国产精彩视频在线观看91 | 久久精品国产亚洲av久一一区 | 华人策略菠菜论坛celue | 国产美女视频网站免费 | 少妇大胆瓣开下部自慰 | 亚洲国产成人精品女久久久 | 午夜性a一级真人片 | 日韩不卡一区二区三区四区 | 日本夜爽爽一区二区三区等精彩节目 | 欧美另类亚洲一区二区 | 人妻思思热精品在线 | 亚洲 日韩 欧美 成人 在线观看 | 18禁毛片免费无遮挡试看 | 2024中文字幕国语免费的 | 婷婷五月天黄色视频 | 91精品无码人妻浪潮 | 蜜桃视频免费 | 中文字幕亚洲伦理一区 | 久久99九九99九九精品 | 日韩欧美国产高清 | 东北50老熟女日出白浆视频 | 日韩精品免费一区二区三区播放 | 95视频在线观看高清免费影院 | 国产午夜福利电影欧美日韩 | 国无码精油按摩在线直播 | 波多野结衣高清久久一区 | 亚洲精品成人无码毛片 | 国产v亚洲v欧美v专区 | 好爽…又高潮了娇喘视频 | 欧美性色欧美a在线播放 | 青青草原精品资源站久久 | 伊人网在线免费观看视频 | 连续热门一级国产a毛精品高清画质亚洲AV最新4K播放 | 久久香蕉人人超人人 | 亚洲一级av无码毛片精品 | 欧美国产日韩欧美在线视视频 | 精品国产性一二三区 | 在线午夜精品一区 | 女儿的朋友在线观看 | 婷婷精品久久免费视频 | 国语自产青青免费精品视频 | 國產又黃又色又粗又大又長 | 16—17女人毛片毛片同性 | 国产一区二区欧美日韩亚洲 | 91在线国产观看 | 国产操逼色网视频 | 苍井空无码在线 | 超级yin荡的人妇 | 国产日韩欧美区二区三区四区 | 影音先锋金发性爱 | 午夜视频在线观看一区二区福利 | 国产亚洲麻豆一卡2卡三 | 亚洲特一级黄色电影 | 精品一区二区免费视频 | 日韩一区二区三区午夜免费视频 | 国产欧美一区二区三区免费观看 | 久久久久一区二区精品 | 国产熟女偷窥一区二区视频 | 国产成人久久综合777777麻豆 | 日日日射射射 | 亚洲精品国产啊啊啊 | 国产黄色精品影院 | 91口爆吞精国产对白a在线观看 | 美日韩无码高清一区二区三区 | 麻豆aⅴ精品无码一区二区 | 国产黄在线观看视频免费 | 免费 无码 国产白丝 | 欧美a一级特黄大片 | 国产一区日本免费 | igao午夜在线视频播放 | 国产一级高清a毛片 | 国产精品自拍亚洲视频 | 性暴行3糟蹋越南女兵 | 色综合色欲色综合一区 | 中文亚洲欧美乱码在线观看資源免費看 | 国自产精品中文字幕亚洲 | 亚洲视频之中文字幕 | 亚洲成人女人精品久久久 | 69堂免费视频啪啪 | 国产美女精品免费在线观看 | 亚洲综合精品一区二区 | 大象AV导航在线 | 国产毛片一区二区三区在线 | 国产一区二区美女自卫 | 色婷婷五月六月综合激情 | 狼友av在线播放 | 黄h欧美1区 2区 3区在线观看 | 乐播四季AV一二三区免费播放 | 69堂免费视频啪啪 | 国产精品一区无码中文字幕 | 一级做a爰片性色毛片久久久特级A√片免费观看 | 日韩免费成人大片 | 亚洲乱码中文字幕综合久久久 | 色狠狠色噜噜AV天堂五区小说 | 国产国产午夜福利 | 精品囯产免费一区二区 | 视频福利国产欧美手机版 | 亚洲精品国产成人精品在线观看黄视频 | 在线视频 一区 色 | 欧美综合婷婷欧美综 | 911国产爱豆剧传媒在线观看 | 国产亚洲欧美成人综合 | 伊人久久大香线蕉一区 | 偷拍走光精品视频一区二区 | 精品麻豆高清一区二区 | 18禁无遮挡啪啪无码网站 | 亚洲日韩一区尤物在线观看手机免费观看 | 亚洲免费在线观看不卡 | 午夜福利国产精品免费 | 狠狠色婷婷綜合天天久久丁香 | 涩涩涩视频在线观看免费 | 色欲视频一区二区三区在线观看 | 午夜国产福利写真视频网站在线 | 9cao在线观看国产 | 中文字幕无码一区二区久久 | 欧美日韩一区二区三区aa | 国产欧美日韩vā另类在线播放 | 大象AV导航在线 | 2018天天日天天射 | 成全视频在线观看免费高清版有多少集? | 人妻αv中文字幕无码 | 二级毛片韩国精品无码 | 日韩资源亚洲精品欧美资源 | 女生你别舔了啊的软件 | 男人桶女人爽羞羞漫画 | 97电影在线观看 | 男女免费在线观看网站 | 伊人久久精品欧洲综合网 | 久久国产成人亚洲精品影院老金 | 亚洲AV无码一区二区三区看 | 肉欲性瘾H强啪总攻1v1医生 | 亚洲精品成人片在线播放互動交流 | 日韩一区二区手机视频 | 日韩日韩精品无砖专区2020 | 精品一卡2卡3卡4卡新区在线 | 亚洲精品国产a久久久 | 无码av在线永久 | 日本A Ⅴ一级中文字幕 | 毛茸茸free性熟妇ad | 亚洲国产中文欧美一区二区综合精品区 | 91偷拍裸体一区二区三区 | 日韩和亚洲的日本品牌区分 | 中文人妻无码一区二区三区信息 | 亚洲专区高清无码 | 亚洲欧美日韩综合在线一 | 狠狠色噜噜狠狠狠狠米奇777 | 亚洲午夜AAA片内谢无码理伦 | 被农民工玩酥的黄小婷 | 中文字幕人妻免费看 | 国产专区欧美专区日韩专区 | 国产免费一a一片一级一片 | 精品91麻豆免费免费国产在线 | 成人久久18免费网站漫画 | 91麻豆精品國產自產在線觀看一區 | 免费 无码 国产白丝 | 午夜在线观看中文字幕 | 99国产一区二区精品久久呦 | 国产精品xxxwww丝袜美女 | 婷婷网色偷偷亚洲的天堂 | 中文字幕亚洲综合麻豆日本 | 岛国av在线播放 | 国产超碰在线观看 | 精品国产高清av自产拍在线妓女 | 伊人AV综合超碰在线小电影 | 无码高清一区二区三区 | 一区二区三区四区欧美亚洲 | 中文字幕吹石奈砱黑人 | 午夜激情在线播放 | 成人污污污视频免费在线观看 | 日韩欧美在线视频一区二区三区 | 又黄又无遮挡无码的免费视 | 國產高清一級夜夜爽 | 久久天天免费一级毛片 | 精品热映电影天堂在线观看免费完整版 | 久久精品欧美日韩精品不卡 | 亚洲欧美日韩文无线码 | 亚洲av色区在线播放 | AV女优视觉盛宴在线 | 日本高清一区二区三区在线观看 | 欧美一区2区三区4区贰佰公司 | 亚洲熟妇国产熟妇肥婆 | 欧美综合色婷婷欧美双茎综合五月 | 精品无码一区二区三区爱欲小说 | 熟妇人妻自拍视频 | 日本一区欧美激情在线观看 | 一级免费毛片免费毛片 | 国产69精品亚洲激情网站 | 狠狠色丁香婷婷久久综合考虑 | 小h片资源免费观看在线 | 香艳69xxxxx有声小说 | 中文字幕+媚药+日韩精品 | 久久精品亚洲天堂av | 日韩欧美综合无尽动漫视频 | 国产精品三级av及在线观看 | 日韩女邻居丰满的奶水在线 | 亚洲精品国产自在现线这里有精品 | 精品人妻毛片久久久久久 | 女人在厨房被添高潮全过程A片 | 少妇人妻精品无码视专页一 | 自拍偷自拍亚洲精品一区 | 无码人妻专区AV一区二区 | 国语自产青青免费精品视频 | 1本2本3本不卡视频 | (凹凸)狠狠综合视频精品播放 | 最新国产口爆视频 | 伊人五香丁香婷婷天堂网 | 欧美片中文字幕一区二区三区 | 大香蕉太香蕉成人现现 | 男人和女人一起打扑克牌app | 青青青免费爽爽久视频 | 在线国语精品视频 | 8888四色奇米在线观看不卡 | 99久久婷婷国产综合精品hsex | 欧洲视频中文字幕在线播放 | 国产精品三级五月婷婷一区 | www.17c嫩嫩草色视频蜜桃 | 久久99ER热精品免费播 | 日韩国产欧美黄片 | 男人添女人下部高潮全视频强奸视频 | 99re6免费视频 这里只有精品 | 欧美亚洲另类精品精品一区 | 在线高清中国videossexo | 国产另类精品久久久久 | 久久久亚洲精品好片 | 国产欧美日韩成人在线观看 | 亚洲精品视频在线观看免费 | 免费亚洲永久一区二区三区 | 丰满大屁股熟妇猛交xxoo | 日本一区二区三区在线免费观看视频 | 最新亚洲中文字幕无码在线 | 不卡在线免费av | 色婷婷综合久久久久中文 | 亚洲毛片欧洲毛片国产一品色 | 乱码国产婷婷综合在线视频 | 毛片网毛片网 | 欧美性爱黄片免费在线观看 | 久热传媒在线免费观看视频 | 性饥渴少妇aV无码毛片 | 日韩精品在线观看1区2区 | 国产国语对白激情视频 | 午夜福利视频91 | 久久99九九99九九精品 | 日韩在线精品人妻中文字幕 | 2020精品国产黄片 | 老师在上课时露出奶头 | 色哟哟在线观看一区二区三区 | 日本在线视频一区二区精品无码毛片 | 一个人免费日韩不卡视频 | 国产a三级AV最新免费黄色网址 | 日韩少妇内射免费播放 | 精品国免费一区二区三中文字幕三级专区 | 亚洲欧美日韩精品a∨高清 | 亚洲一区日韩动漫 | 久草色香视频在线观看 | 韩国三级HD中文字幕三义 | 一级做a爰片久久毛片软件 | 欧美日韩国产一级久久忘忧草 | 亚洲经典 国产精品 | 欧美精品播放色涩在线 | 天天看片亚洲专区手机av | 乱码国产丰满人妻www69 | 欧美字幕第一页 | 久久香蕉视频美女 | 少妇无码免费精品不卡AV专区 | 国产精品久久久91av色婷婷 | 久久精品国产亚洲av搬运工 | 久久久亚洲欧洲av | 免费在线观看亚洲aⅴ日韩a∨ | 91精品国产免费人成网站 | 国产69堂高清精品 | 国产二区欧美精品 | 天天拍夜夜操 | 久久精品国产亚洲av久一一区 | 亚洲日韩中文字幕无码強姦 | 无码蜜桃AV免费久久精品 | 97国产成人精品免费视频 | 色就是色欧美图片一区二区 | 国产呦交精品免费视频无码 | 最新精品国偷自产视频在线观看 | 特级女人十八毛片a级 | 国产午夜大片在线观看 | 国产国语av自拍片 | 国产亚洲精品一本四区91 | 中文与幕中文字幕在线中二区 | 超碰成人免费观看在线 | 色影院不卡中文一区二区 | 中文字幕在文字幕乱码一二三 | 久久99视频免费 | 性欧美日韩国产XXXXX视频 | 在线美女喷水在线观看国产 | 色欲午夜码久久久久久AV码 | 国产精品久久污 | 亚洲精品国产自在现线这里有精品 | 久久国产精品99久久久久久丝袜 | 91尤物国产大尺度福利网 | 国产又粗又大又爽又免费色网视频 | 肉欲性瘾H强啪总攻1v1医生 | 中文人妻无码一区二区三区信息 | 亚洲一区免费av | 在线午夜精品一区 | 最新国内熟女少妇视频 | 黄色天堂视频免费观看完整版高清国语自产精品 | 丁香久久久激情五月天 | 国产欧美日韩二区在线观看 | 波多野结衣一区二区三区av | 亚洲精品动漫一二三区 | 精品日韩在线视频第一区 | 国产成人福利色视频 | 国产一级毛一级毛片 | 国产精品第1页在线播放 | 视频福利国产欧美手机版 | 中文字幕 日韩 欧美 最新 | 放荡的三级护士国产精品主播 | 七海久代中文字幕 | 黄片高清无码在线观看 | 100部乱大合集小说 | 妺妺的荫蒂让我添高潮了视频 | 毛片免费久久久久 | 18禁H漫免费漫画无码网站国产 | 色鬼97悠悠久久综合 | 久久人妻无码一区二区中文字幕 | 一级做a爰片欧美一区 | 人妻激情无码在线 | 特级淫片女子高清视频国产片 | 高清无码日逼视频 | 中文人妻无码一区二区三区信息 | 私人会所黄色片一级的 | 成人精品玖玖资源在线播放 | 欧美性色欧美ä在线在线播放 | 亚洲一卡2卡三卡四卡精品 | 亚洲无码视屏一区二区三区 | 偷自拍亚洲欧美一区二页 | 少妇白浆溢出视频在线观看 | 国内自拍视频在线观看 | A久久精品国产精品亚洲一级毛片 | 日韩手机在线视频观看成人 | 精品亚洲免费久久 | 色婷婷久久精品网 | 精品精品国产av | 日韩中出在线一区二区人妻 | 日韩欧美亚洲中文字幕无色码 | 国产一区二区美女自卫 | 国产极品福利自在线观看 | 亚洲精品三级片在线观看 | 午夜毛片欧美黄色免费 | 亚洲中文乱码在线观看aⅴ | 在线视频福利网站 | 美女美女丝袜视频一区二区三区 | 精品国产AV最大网站麻豆 | 精品盗摄女厕Tp美女嘘嘘 | 中文字幕丰满美人妻ckplayer | 亚洲一区二区三区不卡无码 | 亚州一区二区三区a级片免费观看 | 蜜桃传媒秘色网视频网站 | 黄色小视频在线观看网站 | 97se亚洲综合在线天天 | 中文字幕亚州国产 | av日韩亚洲一区 | 亚洲视频小说之无码 | AV女优视觉盛宴在线 | 久久久久久亚洲精品网址 | 国产成人3p视频免费观看 | 免费女同毛片在线观看 | 91麻豆精品欧美视频 | 惠民福利国产在线精彩视频二区 | a毛片免费全部播放无码视频大全 | 美外成人特级a做片 | 亚洲国产欧美日韩综合久久麻豆 | 九九视频在线观看精品 | 久久99精品成人网站小说 | 日本免费在线观看亚洲 | 日本黄色免费人成视频 | 亚洲 欧洲 日产 韩国网站 | 国产精品xxxwww丝袜美女 | 日产一区二区在线 欧洲 | 午夜国产成人福利片在线观看 | 小鲜肉GARY2023男男 | 城中村嫖妓丰满少妇 | 苍井空无码在线 | 最新国产精品v欧美视频 | 狠狠五月综合婷婷香蕉 | 福利姬国产在线观看免费 | 粉色成视频片在线观看下载 | 国产三级国产精品国产普通话 | 春水堂视频永久网址 | 国产a三级AV最新免费黄色网址 | 后进式无遮挡啪啪摇乳免费 | 无码人妻一区二区三区密桃手机版 | 国产精品一区欧美午夜福利 | 国产www在线免费黄网站 | 亚洲欧美日韩国产手机在线 | 欧美亚洲自拍少妇 | 极品人妻一区二区三区 | 大腿蜜精品在线一区 | 亚洲不卡av中文 | 久久国产精品亚州精品毛片 | 国产有码无码久久久久久久久 | 国产人妻精品一区二区三水牛影视 | a毛片免费全部播放无码视频大全 | 日本特级黄色录像 | 思思久99在热国产丝袜美女一区二区三区 | 日韩不卡一区二区三区四区 | 看片中文字幕一区二区 | 亚洲VA欧美VA人人爽变性人 | 日本不卡中文字幕一区二区三区 | 你懂得2019在线观看网站 | 国自产拍精品偷拍 | 欧美成人午夜 | 2024一级毛片免费观看 | 久久91精品国产91久久戶 | 亚洲高清无码国产 | 免费强角色乳液网站下载 | 精品无码无人网站免费 | 亚洲无码在线观看99 | 手机亚洲视频在线观看 | 欧美日本亚洲 | 日韩欧美极品 | 午夜福利在线第一 | 1024国产精品视频一区 | 女人私密部位高清图片 | 国产精品白嫩美女视频 | 亚洲成人欧美日本电影 | 亚洲Av永久无码精品黑人 | 亚洲旡码A一区二区三区 | 免费无码一区二区三区A片百度 | 国产一区二区三区精品蜜臀 | 日韩欧美精品一区 | 国产亚洲成av人在线观看导航 | 日韩人妻高清一区二区 | aaaa级少妇高潮大片在线观看 | 电击惩罚花蒂榨乳调教小说 | 狼窝午夜福利在线观看 | 国产亚洲精品美女久久久久88 | 国产精品成人免费视频 | 精品日韩原创欧美一区国产 | 亚洲系列日本无码影院 | 国产成人深夜福利在线观看 | 最新国内精品自在自线视频 | 伊人俺去久久涩五月综合 | 亚洲欧美日韩国产精品第不页 | 一色一情一伦一区二区 | 黄色免费无码一二区 | 秋霞午夜理伦电影片影院网在线 | 國內精品一區二區在線觀看 | 日韩 福利 在线视频播放 | 国产精品美女久久久网站 | 亚洲视频一区二区不卡播放 | 国产精品亚洲欧美极品 | 巨大乳首に揉んで乳搾り | 亚洲特黄一区无码 | 蜜桃视频APP下载污 | 国产日韩欧美一区二区三区乱码 | 男女狂乱x0x0动态图 | (愛妃視頻)日韩色免费在线观看 | 亚洲不卡中文无码 | 99国产精品自在自在久久看片 | 91中文有线视频 | 国产精品三级av及在线观看 | 欧美一区2区三区4区网站 | 欧美婬乱片A片AAA毛片地址 | 亚洲中文字幕另类欧美二区 | 成人一区二区av免费播放在线观看 | 挡不住的风情在线观看 | 午夜国产欧美 | 日韩视频免费播放 | caoporm国产精品视频免费 | 中文字幕乱码少妇精品视频 | 91精品国久久久久久无码免费 | 国产精品人妻系列21p | 日本在线免费 | 亚洲熟妇无码A∨在线直播 | 亞洲六月丁香繳情久久丫 | 国产专区欧美专区日韩专区 | 91精品国久久久久久 | 美女美女网站全黄 | 日韩欧美精品国产一区二区 | 国产一区二区美女自卫 | 亚洲色图无码av | 久久精品中文字幕人妻 | 精品少妇大屁股白浆无码 | 深爱激情五月天伊人 | 天天躁夜夜躁狠狠久久 | 天天躁AAAAXXXX日日躁 | 91福利精选在线观看 | 国产videosgratis杂交人禽交 | 在线观看国产成人三级 | 韩国Ⅴ日本V欧美V | 亚洲一区二区三四区 | 欧美性爱网站激情性爱视频 | 亚洲一区二区三四区 | 今天高清视频免费播放中国 | 亚洲一区亚洲二区国产 | 成人国产精品一级毛片电影 | 亚洲国产欧美在线看片一国产 | 精品人妻无码一区二区三区波多 | 日韩制服丝袜无码av | 午夜激情在线播放 | 亚洲系列av无码av一区麻豆 | 国产精品老女人精品视 | 国产99在线观看 | 最新69成人国产精品视频免费亚洲性片 | 717欧美论理电影 | 美女国产欧美日韩 | 亚洲精品中文字幕无乱码麻豆 | 亚洲欧美综合另类天堂网 | 91精品国久久久久久 | 国产成人免费ãV片在线观看 | 把我绑在床头虐奶头 | 亚洲国产综合精品中文第99 | 护士奶头又大又软又好摸 | 亚洲欧洲日韩av综合 | 99久久婷婷国产综精品 | 精品国产乱码久久久久久108 | 欧美日韩性爱视频一二三 | 無碼人妻αⅤ免費一區二區三區 | 欧洲黑丝妓女精品HD | 国产日韩欧美区二区三区四区 | 国产日韩欧美高清分类在线 | 日韩成人免费在线视频 | 婷婷成人AV电影 | 日本亚洲高清乱码中文在线观看 | 欧美成人无砖专区一中文字目 | 国产免费一区二区在线播放 | 成全视频在线观看免费高清版有多少集? | 国产äⅴ激情无码久久久无码 | 久久一级毛片大黄 | XX欧美日韩第一性 | 精品国产自在精品 | 亚洲色精品VR一区二区三区 | 精品视频在线播放不卡 | 免费黄色福利电影 | 五月丁香久久亚洲欧洲日本 | 国产三级黄色av | 国产一级毛一级毛片 | 日本国产亚洲三级 | 老湿机一区二区三区 | 男人天堂久久 | 午夜久久久久久久久 | 男进女内免费视频无遮挡 | 欧美日韩精品人妻一区 | 亚洲Aⅴ福利天堂导导航 | 久久成人国产精品 | 亚洲一码二码三码精华液 | 大屁股美女视频国产免费 | 国产精品一区无码中文字幕 | 久久午夜夜伦鲁鲁片无码免费播放区 | 天天噜噜噜在线视频 | 九九在线视频精品视频 | 97人人爽亚洲国产精选麻豆 | 久久一区二区三区种子电台中文字幕 | 国产极品精品婷婷久久精品 | 精品自产拍在线观看二区 | 日本免费在线网址 | 欧美人与动zozo | 欧美国产日韩三级 | 午夜在线播放免费人成年 | 日韩一品欧美一区 | 日韩精品免费一区二区三区播放 | 黄www羞羞视频在线观看 | 亚洲 欧美 日产在线播放 | 在线日本看片免费人成视久网 | 亲嘴揉胸口激烈视频 | 精品国产综合乱码久久久久久 | 国产系列久久影院 | 亚洲AV日韩AV无码尤物 | 欧美日韩国产一区二区免费 | 国产全黄三A级 | 每日更新不卡av首页 | 久久这里只精国产 | 日韩大乳视频中文字幕 | 国产欧美日韩vā另类在线播放 | 将军灬啊灬啊灬轻点野外 | 四虎免费最新在线永久4HU | 一级a视频在线免费观看 | 国产一区二区三区精品观看 | 亚洲伊人tv综合网色 | 梦乃爱华作品在线观看播放 | 一区二区三区免费视频不卡 | 亚洲最的成视频在线观看免费 | 成人无码国产一区二区在线播放 | 日本一区二区三区欧美国产 | 精品国产亚洲午夜精品av99 | 精品国产亚洲成人人在线 | 欧美一级a爱片免费观看看 | 99967pao国产成视频永久免费 | 三级片中文网站日日爱 | 亚洲一区二区三区久久不卡 | 亚洲无码性爱视频网站 | 中文字幕亚洲手机在线视频 | 日韩一区二区三区午夜免费视频 | 亚洲中文字幕无码一二三四区 | 中日无码在线激情视频 | 达达免午夜起神影院 | 亚洲第一中文字幕 | 2024一级毛片免费观看 | 日韩av成人永久无在线观看激情 | 亚洲高清AV无码免费在线观看 | 十八禁免费视频在线播放 | 久久国产亚洲精选AV | aa级女人大片喷水视频 | 婷婷精品久久免费视频 | 久久精品国产亚洲āV蜜臀色欲一级毛片 | 色欲久久久天天天综合网欧美 | 国产一级婬片AAAA片无码 | 天天澡天天添天天摸97影院 | 欧美日产精选自拍 | 涩涩涩视频在线观看免费 | 日本护士视频欧美人妻 | 色大成网站www久久九九 | 12周岁女全身裸啪啪自慰网站 | 久久久久国产精品人 | 国产a三级AV最新免费黄色网址 | 五月天久久精品国产亚洲av | 国产日产欧产精品精品首页 | 亚洲精品高清女同中文字幕 | 精品不卡一区2021 | 夜夜爽快夜夜欢乐av | 青青青青青国产免费手机看视频 | 国产三级国产精品国产普通话 | 美日韩无码高清一区二区三区 | av不卡网久久久久久久久久 | 国内爽视频一二三区视频 | 8090成人午夜精品 | 国产精品久久久久久一二三四五 | 日本最新黄色网址 | 国产欧美vÄ欧美vÄ香蕉在线 | 成人偷乱人伦精品视频网站 | 久久精品蜜芽亚洲国产AV无码 | 免费一级a毛片在线视频播放 | 国产一区二区精品观看 | 精品国产一区二区三区无码乌克兰 | 邻居勃起人妻忍不住中文字幕 | 久久草草综合精品导航 | 国产大片精品久久 | 东京热无码一级大毛片 | 99热久久视频只有精品在线 | 麻豆黄软件在线观看 | 亚洲视频影院 | 秋霞国产午夜精品免费 | 国产91久久精品成人看 | 国产精品美女在线专区 | 久久亚洲日韩成人无码 | 亚洲人妻日韩欧洲中文字幕 | 春色校园综合人妻AV | 亚洲网站嗯啊 | 国产A级一级毛片 | 精品中文字幕国产91久久一区黄无码 | 亚洲AV无码乱码在线观看韩国 | 自拍偷拍淫荡人妻 | 日韩一区二区三区综合色区 | 成人一区二区丝袜美腿 | 在线乱码一卡二卡麻豆 | 日日日射射射 | 精品无码成人片一区二区98 | 草b视频在线观看 | 亚洲日韩无遮挡无码久久 | 日韩中文字幕欧美日韩亚洲第一区 | 国产特黄观看视频 | 亚洲欧美成年a级片 | 亚洲乱亚洲乱妇22p | 欧美日韩一区二区交流 | 午夜亚洲福利av | 一级毛片试看60分钟免费高清观看 | 欧美精品久久一级cad片 | 亚洲一区日韩动漫 | 欧洲视频中文字幕在线播放 | 精品国产一区一区二区三亚瑟 | 欧美三日本三级少妇99 | 精品久久久国产福利 | 中文字幕乱码人妻波多野结衣 | 一区二区三区AV | 影音先锋午夜AV在线 | 亚洲无码在线观看视频免费 | 国产精品xxxwww丝袜美女 | 人妻αv中文字幕无码 | 亚洲欧美日韩成人高清在线一区 | 粉嫩小仙女扒开自慰喷水图片 | 久久国产精品精品国产九九 | 一区二区美女在线视频 | 97人人爽亚洲国产精选麻豆 | 国产精品第九页在线观看 | 亚洲熟女乱色一区二区三区丝袜 | 欧洲免费看片尺码大 | 综合亚洲免费中文 | 中文国产日韩亚洲 | 99成人在线免费视频 | 91AV资源网站在线播放 | 天天摸夜夜添狠狠添高潮出 | 天天操夜夜操综合网 | 91看片无码视频第40页 | 茄子污网站下载不充钱 | 在线亚洲AV成人无码一区小说 | FUCK国产精品一区 | 日本三级在线观看网址 | 久久影院精品国产 | 亚洲AV无码鲁丝国产精品午夜站 | xxx国产性按摩www性爽欧美 | 国外成人免费在线视频 | 中文人妻无码一区二区三区信息 | 亚洲区自拍偷拍视频 | 日韩中文字幕欧美日韩亚洲第一区 | 一级做a爰片性色毛片久久久特级A√片免费观看 | 曰本久久久久久久黄色视频 | 國產性夜夜性夜夜爽91 | 全部免费毛片在线午夜裸体美女爆乳福利视频 | 日韩精品人妻专区 | 日韩日韩精品无砖专区2020 | 了解最新国产亚洲精品片a77777 | 欧美日韩精品久久久免费观看 | 日本视频在线观看一区二区三区 | 小鲜肉自慰网站 | 午夜天天福利小视频 | 再把腿X开一点就可以吃扇贝 | 日本国产网红亚洲视频啪啪 | 老板含着她的花蒂啃咬高潮的视频 | 午夜国产人人精品一区 | 亚洲加勒比久久88色综合 | 国产自偷频在线观看 | 2012中文字幕电影 | 亚洲欧美综合影视 | 国产精品无码不卡午夜 | 成人精品电影一区二区三区 | 中文一区二区视频 | 久青草国产97香蕉在线视频 | 亚洲日韩国产av无码精品色午夜 | 免费观看全黄做爰大片 | 狠狠做开心五月综合 | 亚洲欧美日韩文无线码 | 天天影视久久综合综合久久 | 变态美女免费视频网站 | 亚洲国产中文成人九九综合 | 久久激情综合五月天 | 又粗又硬又黄又爽视频 | 亚洲成人午夜福利网站 | 丝袜无码专区人妻视频 | 亚洲一码二码三码精华液 | 校园春色自拍偷拍亚洲 | 在线视频 一区 色 | 国产偷窥熟女高潮精品视频免费 | 青于乐在线毛片免费观看 | 后进式无遮挡啪啪摇乳免费 | 在线 亚洲 校园 在线 无码 | 免费日韩久久无码中文字幕 | 成人av久久一区二区三区 | 亚洲AV成人无码网在线看 | 久久99国产麻豆一区二区三区网站 | 久久99国产高清亚洲观看 | 女人自慰全过程免费看 | 久久国产精品一区二区三区视频 | 97人妻人人做人碰人人爽流奶水 | 精东传媒vs天美传媒合作 | 日本亚洲高清乱码中文在线观看 | 国产精品一区2区久久 | 亚洲成人午夜在线影院 | 久久午夜夜伦鲁鲁片无码免费播放区 | 韩国理仑片色情大全电影在线观看 | 欧美综合区自拍亚洲综合天堂 | 51久久国产露脸精品国产 | 强开乳罩摸双乳吃奶羞羞漫画 | 91福利精选在线观看 | 日韩国产成人无码a毛片 | 欧美日韩精品一区二区在线播放蜜臀 | 91精品国产免费人成网站 | 国产精品无码综合网 | 国产在线观看精品免费 | 99九九精品视频 | 18禁无遮挡啪啪无码网站 | 亚洲视频影院 | 久久六免费视频免费观看 | 精品国偷自产一区2区三区久久 | 久久婷婷五月综合尤物色国产. | 91精选视频在线观看 | 不卡日本中文字幕在线 | 日韩欧洲亚洲午夜久久久 | 日本欧美极品视频 | 日韩中文字幕网站 | 一级做a视频久久久免费 | 亚洲国产欧美日韩综合久久麻豆 | 亚洲国产精品一区二区成人小说 | 亚洲 日韩 欧美 成人 在线观看 | 成人免費觀看www視頻 | 亚洲精品日韩三区 | 国产系列久久影院 | 日韩精品中文字幕亚洲一区 | chinese实践打屁股视频网站 | 国产日韩欧美一区二区三区乱码 | 欧美一线不卡在线播放 | 亚洲精品AⅤ无码精品丝袜无码 | av网址大全性久久久 | 日韩AV无码精午夜精品 | 久久久亚洲精品国产亚洲ÁV女同 | 亚洲精品AⅤ无码精品丝袜无码 | 日本一区二区三区久久精品 | 欧美成人无砖专区一中文字目 | 爱人韩国电影完整版 | 一级无 码在线观看 | 免费婬色男女乱婬视频国产网 | 欧美日本黄色一区二区三区 | 精品中文字幕久欧美日韩在线观看无需下载手机在线观看 | 亚洲午夜无码久久久久网 | 欧美在线日韩在线国产在线 | 国产户外调教视在线播放 | 一级毛片试看60分钟免费高清观看 | 久久精品国产亚洲ąV无码麻豆 | 亚洲一区二区成人片在线观看 | A久久精品国产精品亚洲一级毛片 | 免费看成人国产一区二区 | 国产三级片一区二区精品在线观看 | 无码午夜在线播放 | 亚洲中字无码手机在线电影 | 国产在线观看人成激情视频 | 99久久久国语露脸精品国产麻豆 | 日本妇人成熟A片免费观看 | 男女啪啪啪猛烈无遮挡 | 国产情趣免费视频在线观看 | 亚洲区无码日韩品精一区 | 亚洲无码一区盗摄土豆 | 日韩国产av二区 | 上海艺校校花被猛艹在线观看 | 欧美亚洲国产主播在线观看 | 亚洲AV无码国产乱色欲 | 免费无码国产污污观看 | 大屁股美女一级毛片 | a级毛片无码免费观看 | 久久久精品成人免费观看国产 | 欧美一区二区中出 | 97热久久免费频精品99… | 欧美另类偷自拍情纯唯美 | 亚洲精品中文字幕无乱码麻豆 | 91AV资源网站在线播放 | 亚洲AV秘片一区二区三区 | 永久免费av片在线观看全网站 | 视频一区二区村上凉子 | 欧美a在线观看 | 一区二区三区高清视频观看 | 亚洲AV秘片一区二区三区 | 伊人久久大香线蕉网精品 | 国产高清免费一级视频播放在线观看 | 自慰少妇裸体无码30p | 精品人妻大屁股白浆宅男 | 国产视频成人在线 | 国产国产人免费人成免费视频下载 | 午夜在线免费观看小视频 | 国精一二三区别免费观看 | 无码中文人妻在线一二区 | 国产一区二区三区av无码 | 久久人妻无码一区二区中文字幕 | 亚洲AV秘无码不卡在线观看 | 无码人妻专区AV一区二区 | 婷婷网色偷偷亚洲的天堂 | 久久久久久久精品9999成人热 | 精品亚洲国产成人av在线 | h肉动漫无码无修6080动漫网 | 综合色区偷拍 | 久久精品午夜无码2017 | 日韩在线精品人妻中文字幕 | 国产色和在线视频 | 日韩欧美中文久久按摩视频 | 亚洲美女在线视频福利 | 久久精品国产亚洲āV蜜臀色欲一级毛片 | 国产免费一区二区在线播放 | 性生交大片免費看女人按摩 | 日韩欧美中文久久按摩视频 | 久久伊人狠狠 | 欧美第一大尺度视频 | 久久免费看少妇高潮a片麻豆 | 久久亚洲a∨无码精品色午夜麻豆 | 黄色视频免费在线观看网址 | 日本乱偷中文字幕久久久 | 寂寞少婦被猛烈進入在線兔費觀看 | 国产福利成人片源movies全集无删 | 欧美激情男人的天堂 | 国产日产欧美欧韩在线 | 國產免費人成在線視頻視頻 | 国产视频一区二区三区在线观看免费 | 欧美性猛交xxxx乱大猛交3 | Jizz国产精品护士日本国产 | 爽爽无码18禁免费国产 | 国产精品sss在线观看av | a毛片免费全部播放无码视频大全 | 国产日韩欧美一区二区视频在线观看 | 小早川怜子在线视频欧美激情 | 国产一区二区波多野结衣在线看 | 欧美日韩人妻一区二区三区视频 | 成人福利在线免费观看 | 国产一级在视频在线观 | 欧美亚洲国产精品久久 | 国产91欧美成人免费观看 | 免费网禁呦萝资源网视频 | 国产亚洲欧美精品电影 | 日韩欧美极品 | 91AV资源网站在线播放 | xxx国产性按摩www性爽欧美 | 欧美亚洲精品福利免费专区 | 91一区二区无码水蜜桃人妻 | AV影视免费观看麻豆 | 国产特级毛片一级毛片国产 | 福利片国产乱视频伦在线 | 亚洲熟妇无码A∨在线直播 | 亚洲麻豆久久一区 | 日韩欧美亚洲中文字幕无色码 | 中文字幕亚州国产 | 男人天堂久久 | 久久精品亚洲国产片 | 国产亚洲成av人在线观看导航 | 3D动漫无码AV禁在线无码 | 福利片精品福利片 | 亚洲AV日韩AV无码AV另类小说 | 国产真实老熟女无套内射 | 黄色亚洲传媒一级片一区二区三区 | 午夜小视频在线观看欧美日韩手机在线 | 精品无码人妻一区二区免费16 | 国精一二三区别免费观看 | 亚洲欧美综合茄子 | 国产极品粉嫩馒头一线天图片 | 精品国产综合Av无码久久久 | 久久久高校女厕所偷拍视频 | 国产高清在线精品一区app | 成人一区二区av免费播放在线观看 | 一級特黃AA毛斤 | av免一二三四码蜜桃 | 黄片在线永久免费观看 | 国产真人一级片一级特黄高清aaaa大片 | 青草久久久久国产精品色吧 | 98久久人妻少妇激情啪啪 | 亚洲AV成人无码网站18禁网址 | 欧美亚洲一区二区三区综合区 | 思思久99在热国产丝袜美女一区二区三区 | 羞羞午夜日韩AV电影 | 国产性爱精品家庭乱伦视频免费观看 | 欧美精品啪啪一区二区 | 自拍偷拍区一区二区 精品区 | 欧美日韩免费一区二区在线观看 | 国产av福利久久精品can二区 | 亚洲国产欧美一级影片 | 日韩专区无码专区 | 少妇无码AV无码专区线Y | 三级黄色网址 | 一本大道heyzo无码专区 | 国产精品三级毛片视频 | 2023国产精品高清久久 | 青青草原精品资源站久久 | 国产人成午夜免免费观看 | 无码av综合网国产精品 | 久久久手机版社区放荡免费 | A级国产乱理伦片在线观看Al色戒 | 在线国产视频一级片哪里看 | a级毛中文字幕无码 | 日韩无码中字一二三区 | 中文字幕在线欧美日韩在线播放 | 日韩在线开心五月 | 欧美性受极品xxxx喷水 | 96久久夜色精品国产九色杨思敏 | 精品久久亚洲一区二区三区 | 在線觀看精品國產 | 一本色道无码AV竹菊影视 | 男女做A级毛片视频免费 | 国产午夜福利视频在线播放 | 亚洲一级av无码毛片精品 | 最新69成人国产精品视频免费亚洲性片 | 不卡久久精品国产亚洲av麻豆 | 久久精品国产a真人一级无码毛片一区二区 | 农村妇女一级毛片久久 | 精品无码一区二区三区爱欲小说 | 他原本的午夜福利电影无码专区 | 40厘米黑人与中国女人 | 免费高清无码在线观看 | 男人边吃奶边做边爱免费 | 婷婷一区二区三区综合 | 欧美性爱高清视频在线免费 | 精品久久久无码一二三区 | 一本大道heyzo无码专区 | 伊人久久亚瑟综合 | 色成人网站www永久免费观看 | 久久一级毛片大黄 | 91中文有线视频 | 精品国产美女一区二区三区 | 午夜蜜桃av精品影院无码小说 | 亚欧视频在线观看视频 | 久久精品国产av一区 | 91熟女精品视频 | 久久精品国产99久久久 | 色就是色欧美图片一区二区 | 久久视频在线视频精品 | 欧美日韩第一第二区 | 国产专区尤物极品在线 | 小雪被老汉各种姿势玩 | 国产成人精品视频A片免费观看 | 色综合天天综合网中文伊 | 梦乃爱华作品在线观看播放 | 久久99欧美激情 | 97久久精品人人槡人妻人人玩0 | 亚洲国产成人国产尤物在线播放 | 亚洲vodafone精品性 | 亚洲日韩a¢¥在线视频 | 野花社区一本自拍乱拍 | 最新国产口爆视频 | 国产成人3p视频免费观看 | 国产一级在视频在线观 | 美女粉嫩喷射高潮99视频 | 首页国产熟女一区二区 | 1024人妻无码中文字幕 | 国产精品午夜亚洲 | 欧美三级大片在线播放 | 亚洲成人午夜福利网站 | 婷婷久久人人爽人人爽 | 精品人妻无码一区二区suv免费AV | 在線觀看精品國產 | 91桃色在线网站免费老司机 | 亚洲金发白嫩在线播放 | 一区二区三区午夜片 | 极品少妇高潮xxxxⅹ | 国产精品久久久91av色婷婷 | 97超级碰碰碰久久久久总站 | 99精品和95优品 | 精东传媒vs天美传媒合作 | 亚洲影视天堂 | 中国黄色网站在线观看 | 麻豆网站视频免费在线观看 | 乱人伦视频中文字幕预告片 | 夜色88v精品国产 | 嘟嘟丰满久久久尤物5566高清 | 色影院不卡中文一区二区 | 可以在线观看的黄色网址 | 亚洲无玛中文字幕久久婷婷 | 免费色老久久精品 | 日韩欧美亚洲片 | 粉色成视频片在线观看下载 | 日本少妇自慰一区二区 | AV影视免费观看麻豆 | 青青草原无码视频 | 欧美综合中文乱伦 | 国内外精品成人免费视频 | 国产又黄又大又粗 | 高潮黄色美女网站在线观看 | 国产欧美成人精品www | 国产xxxx视频免费播放 | 日韩国产成人无码a毛片 | 国产字幕中文无码迅雷下载 | 涩涩视频在线免费观看 | 亚洲人成手机电影网站 | 一区二区乱码中文字幕免费视频 | 日韩精品女视频在线观看 | 亚洲一级av无码一级久久精品免费 | 北条麻妃做爰高潮狂喷视频 | 韩国亚洲精品A在线无码 | 欧美国产内射夫妻大片 | 强奷有码在线播放 | 亚洲精品国产成人精品在线观看黄视频 | 国产午夜精品国产 | 欧美激情高潮无遮挡 | 少妇高潮惨叫久久麻豆传 | 国产福利在线视频尤物tv | 岛国片在线观看91 | 亚洲无码之亚洲性爱 | 黑人又粗又大一区二区 | 又大又黄又粗又硬的免费网站 | 国产a毛片高清视频日日愛 | 青草久久久久国产精品色吧 | 韩国三级《我的女友2》 | 国产美女一区二区三区四区 | 免費無碼成人AV在線播 | 终于进去了小婷身体 | 久久夜色精品国产小说 | www免费视频在线观看播放 | 三级色网免费网站 | 大粗鸡巴久久久久久久久 | 国产呦交精品免费视频无码 | 日韩秋霞电影在线视频观看 | 国产偷窥熟女高潮精品视频免费 | 在线视频播放免费网站视频在线 | 日韩一区二区三区四区五区 | 久久99精品成人网站小说 | 国产欧美人与动人物xx视频 | 草莓视频APP免费在线观看 | 麻豆国产av尤物av一区二区 | 无码毛片区免费A∨视频 | 视频福利国产欧美手机版 | 成人一区二区精品在线 | 日本熟妇hd人妻 | 喜爱夜蒲2卫生间做爰 | 青柠影院日韩一三区 | 女xx00高潮动态图 | 5g国产在线探花麻豆传 | 午夜熟女插插XX免费视频 | 国产精品一伊人久久大焦线综合视频 | 日本天堂中文字幕有码 | 欧美亚洲综合精品区 | 日本高清激情乱一区二区 | 在线无码免费网站永久 | 中文在线视频中文国产中文字幕 | 青草草草草在线视频 | 91秦先生久久久久久久 | 中文字幕日韩电影亚洲电影 | 一级做a爰片久久真人片真人片 | 日本亚洲欧美一区二区不卡在线 | 好涨好爽好硬免费视频国产 | 色综合久久网女同蕾丝边 | 国产性色αv视频免费观看 | 日本福利片秋霞国产午夜 | 久久精品国产一区二区三区日韩 | 粉色视频免费高清下载观看 | 男女国产精品久久久 | 中文字幕日韩性感少妇一级免费视频 | 国产情侣普通话刺激对白 | 九九99热久久精品66中文字幕 | 久久精品国产一区二区三区日韩 | 人八碰人人爱免费 | av在线免费不卡直接看 | 亚洲国内精品自在自线国产精品 | 国产精品扒开腿做爽爽爽下载 | 国产亚洲成av人在线观看导航 | 亚洲区日韩区主播传媒 | 秋霞午夜理伦电影片影院网在线 | 成人网无码av视频在线观看 | 亚洲avav天堂av在线 | 性色A∨视频国产调教在线观看 | 免费女人一区二区三区 | 2020国产综合在线入口 | yellow中文字幕熟女 | 视频一区日韩欧美 | 尤物精品国产第一福利三区 | 国产一区二区美女专区 | av日韩在线播放中文字幕 | 91中文有线视频 | 精品国产一区二区三区久久久蜜臂 | 国产免费一级视频在线 | 午夜性色福利视频久久 | 欧美人与动牲交ZOOZ3D | 一级毛片免看国产 | 精品偷拍视频网站 | 亚洲AV无码鲁丝国产精品午夜站 | 日本韩国欧美一二三 | 2018天天躁夜夜躁狠狠躁ap | 中文国产日韩亚洲 | 激情A∨无遮挡在线看 | 在线日韩中文字幕视频 | 在线无码人妻91色在线 | 琪琪电影午夜理论片在线观看6080 | 正在播放无套粉嫩久久久久久 | 美女扒尿口让男人桶动态图 | 不卡日本中文字幕在线 | 国产毛片一区二区三区在线 | 葵司清纯若妻按摩SSNI129 | 玩隐私位置游戏的好处 | 久久疯狂做爰xxxⅹ高潮攻略 | 制服丝袜自拍另类第1页 | 日本aaaa在线观看 | heyzo无码综合伊人精品 | 亚洲伊人区伊伊综合网 | 欧美亚洲国产主播在线观看 | 2012中文字幕电影 | 日本一道一区二区美利坚欧美 | 天天澡天天添天天摸97影院 | 2021亚洲а∨天堂在线 | 久久丫精品国产免费 | 日本无码人妻熟妇人妻av | 日本一区二区三区日本视频 | 高潮黄色美女网站在线观看 | 精品国产性色无码A v网站 | 一区二区三区国产高清在线视频 | 久久久久精品久久九九 | 精品一区二区三区在线观看婷婷 | 国产精品免费大片久久久国产一区二区三区 | 国产三级片一区二区精品在线观看 | 日韩一区二区少妇视频 | 亚洲午夜在线免费 | 在线综合亚洲欧美青青 | 又大又黄又粗又硬的免费网站 | 亚洲欧美综合一区二区 | 不需要付费的污软件 | 午夜一区二区免费福利麻豆 | 韩国的无码av看免费大片 | 日韩欧美视频免费在线观看 | 国内高清无码视频在线 | 国产乱妇无码大片在线观看免费 | 午夜爽爽性刺激一区二区视频av | 国产亚洲精品免费看 | 免费观看一级a愛视频网站 | 日韩资源亚洲精品欧美资源 | 精品亚洲国产电影在线播放 | 亚洲 日韩 欧美 成人 在线观看 | 性爱高清无码午夜 | 亚洲精品成人片在线播放互動交流 | 非洲免费毛片视频播放 | 久久中文字幕无码专区 | 午夜精品АⅤ天堂中文在线 | 亞洲國產精品無碼久久98 | 国产成人一区二区三区影 | 一区二区三区四区欧美亚洲 | 国产成人精品一区二三区 | 成人国产综合av | 日韩精品一区二区亚洲A∨观看 | 中国大成色www永久网站 | 亚洲综合在线一区高清在线观看 | 国产麻豆剧传媒精品国产剧 | 护士奶头又大又软又好摸 | 黄片在线永久免费观看 | 调教侵犯小男生(h) | 大伊香蕉精品视频在线观看 | 男人gaygay免费网站 | 高潮喷水的毛片 | 影音先锋av成人无码电影 | 欧美日韩国产经典一区 | 国产成人av在线播放电影 | 免费日韩电影在线观看 | 俄罗斯精品18videosex性 | 日韩在线AⅤ视频 | 蜜桃视频APP下载污 | 国产福利不卡在线观看视频 | 色哟哟在线观看一区二区三区 | 高清h片欧美人妻 | 国产伦精品一区二区三四区 | 一级毛片无码视频播放 | 99热最新免费获取网址 | 青青青热久免费精品视频 | 特级西西4444WWW无码 | 亚洲国产精品国自产拍AV麻豆 | 欧美三级在线观看中文 | www.17c嫩嫩草色视频蜜桃 | 幺女幺女国产一级中文毛片在线看 | 一级做a爰片性色毛片久久久特级A√片免费观看 | 男生和女生一起怼一怼软件 | 性xxxx歐美老婦胖老太性多毛 | 精品国偷自产一区2区三区久久 | 国产69堂高清精品 | 国产最爽R片在线观看 | 97大神超碰在线中文字幕 | 精品久久久香蕉国产 | 亚色网站在线免费观看 | 国产欧美日韩一级在线视频 | 91大神娇喘女神疯狂在线 | 国产精品无码一区 | 日韩福利免费在线观看 | 99热最新免费获取网址 | 2024天天拍拍天天爽视频 | 高清一级a爱免费视频 | 国产av亚洲精品久久久久 | 午夜性a一级真人片 | 中文字幕综合久久2021 | 国产乱对白刺激视频动态 | 极品国模无码国产在线观看 | 最新69成人国产精品视频免费亚洲性片 | 色哟哟视频在线观看免费播放 | 日本午夜大片免费观看视频 | 午夜国产人人精品一区 | 高潮喷水在线观看免费 | 女人把牛鞭放进下面 | 制服丝袜自拍另类第1页 | 色婷婷综合久久久久中文 | 上司部长出轨漂亮人妻 | 国产一级一级毛片真人视频男 | 韩国R级19禁未删减版 | 午夜精品久久久久99热 | 免费一级无码视频 | 日韩欧洲亚洲午夜久久久 | 在线国语精品视频 | 国产精品嫩草影院人体模特 | 视频福利国产欧美手机版 | 亚洲中文成人av一区二区 | 国产字幕中文无码迅雷下载 | 亚洲精品aaa乱码 | 中文字幕成人免费高清在线 | 亚洲精品久久国产精品37P | 国产精品无码不卡午夜 | 人人91操操操人人人操操操 | 精品热映电影天堂在线观看免费完整版 | 99精品热视频在线观看 | 不卡久久精品国产亚洲av麻豆 | 亚洲精品日韩片无码中文字幕一级免费 | 歐美日韓綜合一區 | 欧美综合色婷婷欧美双茎综合五月 | 欧美午夜成午夜成年片在线观看 | 免费女同毛片在线观看 | 在线观看高清黄网站免费视频 | 欧美精品久久久久免费观看 | 无码中文人妻精品2020 | 久久一区二区三区种子电台中文字幕 | 国产精品视频一区二区首页 | 久久深夜视频 | 99愛視頻精品免視看 | 国产福利成人片源movies全集无删 | 欧美日韩国产亚洲视频 | 无码观看在线电影 | 污片无码在线影院浪潮AV | 免费va欧美在线观看 | 国产色AV一区二区 | 激情五月天亚洲自拍 | 国产午夜精品福利久久网站 | 古代全部一级毛片在线完整版 | 日韩人妻系列无码专区麻豆 | 精品一区二区免费视频 | 亚洲人妻日韩欧洲中文字幕 | 精品国产白丝班长久久久久 | 香蕉网久久综合影院 | 一区二区不卡在线 | 校园春色自拍偷拍亚洲 | 无码äV综合网国产精品 | 无码国产āV精品一区二区 | 将军灬啊灬啊灬轻点野外 | 四虎影库在线播放 | 一级做a爰片久久真人片真人片 | 2020国产成人综合网 | 国产啪啪啪啪啪啪电影观看 | 亚洲日韩欧美制服精品二区 | 黄色无码视频在线看 | 精品无码二区自慰 | 亚洲高清日本一区二区 | 福利片国产乱视频伦在线 | 16—17女人毛片毛片同性 | 国产亚洲电影在线 | 亚洲日韩中文字幕区 | 亚洲一区天堂 | 国产成人αv一区二区三区四区 | 九一香蕉国产线理论片福利 | 思思久久96热在精品国产精品 | 老板含着她的花蒂啃咬高潮的视频 | 精品中文字幕久欧美日韩在线观看无需下载手机在线观看 | 精品国产av无码久久久e | 男人把女人桶到爽免费看视频 | 亚洲a∨好看av高清在线观看 | 北条麻妃做爰高潮狂喷视频 | 亚洲毛片欧洲毛片国产一品色 | 男人添女人下部高潮全视频强奸视频 | 羞羞无码视频在线免费播放 | 日韩永久在线观看免费 | 国产精品国产三级国产a∨中文 | 日韩精品在线网站 | 四虎影在永久地址在线观看 | 老男人久久青草AV | 国产精品.久久久 | 日本少妇中文欧美 | 免费看又黄又无码的网站草草久久久无码国产专区 | 一区二区三区高清视频观看 | 婷婷色综合成人成人网小说 | 久久国产精品福利一区二区三区 | 四虎影视1515hh四虎免费 | 黄色国产色在线剧情 | 欧美日韩一区二区交流 | 欧美国产日韩欧美在线视视频 | 欧美日本黄色一区二区三区 | 一区二区三区国产高清在线视频 | 亚洲乱码中文字幕综合久久久 | 欧美一级二级在线观看视频 | 亚洲色欧美国产综合 | 日韩欧美亚洲中文字幕无色码 | 91精品人妻一区二区 | 亚洲日本久久久久婷婷 | 亚洲中文无码av永久 | 欧美日韩一区二区三区aa | 亚洲欧洲成人一区二区三区 | 小SAO货JI巴CAO死你视频 | 惠民福利亚洲国产一区二区a毛片 | 91熟女精品视频 | 國產精品視頻二區不卡 | 女人久久www免费看片 | 国产毛片啊久久久久久 | 色在色在线播放亚洲中文 | DVD原版蓝光版中文字幕包 | 精品国产亚洲亚洲一级毛片 | 久久免费看少妇高潮a片麻豆 | 9精品国产91久久久无码牛 | 亚洲AV永无码精品一区二区国产 | 国产男女猛烈无遮挡免费观看网站 | 亚洲日韩a¢¥在线视频 | 自拍高清亚洲影视 | av日韩在线播放中文字幕 | 国产偷Ⅴ国产偷V精品视频 | 成人午夜视频观看 | 60岁熟女一区二区 | 国产电影一区二区 | 天堂在线国产 | 国产乱子伦精品免费无码专区 | 亚洲精品日韩三区 | 国产成人无码精品九九九免费 | 日本亚洲欧美一区二区不卡在线 | 今天高清视频免费播放中国 | 久久一区二区三区种子电台中文字幕 | 国产精品欧美丁香五月天 | 日韩欧美综合在线另类 | 久热精品三区亚洲热香蕉在线观看 | 日韩女邻居丰满的奶水在线 | 国产免费一a一片一级一片 | 成年女人看片免费视频74 | 日本在线免费 | 香蕉禁止视频免费看 | 色食软件app下载 | 精品91麻豆免费免费国产在线 | 国产精品无码久久蜜臀av | 亚洲a级无码在线播放 | 国产一级AAA精品免费看 | 亚洲二区亚洲国产综合专区在线电影 | 在办公室拨开老师内裤进入 | 国产成人午夜无码精品免费看 | 久久久国产精品免费免费 | 成人在线播放视频免费 | 久久久久久亞洲精品不卡 | 天天摸天天做天天爽视频 | 榴莲APP榴莲色榴莲18岁 | 野花精品国产亚洲AV | 国产日韩欧美一区二区三区乱码 | 国产婷婷久久一区 | 一级做性色a爰片无码久久毛片 | 亚洲无码之亚洲性爱 | 亚洲人成影院在线观看 | 狠狠色狠狠色综合日日不卡 | 亚洲av无码一区二区在线 | 色窝窝无码一区二区三区成人网站... | 特级婬片国产高清 | 国内自拍视频在线观看 | 日韩人妻制服乱码一区二区 | 国产一区二区yy精品无码毛片 | 精品国免费一区二区三中文字幕三级专区 | 欧美大黄永久免费播放 | 成人制服在线观看 | 亚洲欧洲成人一区二区三区 | 亚洲天堂无码av在线天堂 | 亚洲国产一区二区a毛片变态 | 在线看片免费人成视频在线影院无码 | 少妇高潮一区二区三区99欧美 | 99久久精品蜜臀色欲 | 国产精品99久久久久久人夜夜嗨 | 好吊妞988这里只有精品 | 亚洲视频自拍偷拍精品无码 | 无码免费观看视频 | 91久久精品国产亚洲ą∨麻豆 | 色综合 日本 一区二区 | 国产精品三级下载 | 国产免费免费人成视频网址 | 欧美日韩永久久一区二区 | 国产一区二区美女自卫 | 国产一级婬乱A片无遮精产品 | 免费av网站大全久久 | 91尤物国产大尺度福利网 | 久热这里只有精品视频在线 | 国产特级毛片ääääää毛片 | 高清无码日逼视频 | 欧美日韩精品一级高清 | 亚洲自拍色在线观看 | 天天看片亚洲专区手机av | 中文字幕无码免费2020 | 午夜小视频在线观看欧美日韩手机在线 | 69久69久久高清一区二区三区 | 午夜欧美精品久久久久久懂色 | 2020国产成人综合网 | 99久久精品这里只有精品 | 欧美激情欧美精品色欲少妇 | 国产乱淫片Av免费看 | 午夜福利精品一区二区在线 | 国产精品18久久久久不卡 | 亚洲欧美区一区二区三区四 | 精品国产福利一区二区 | 区一区二国产精品 | 国产97超碰人人做人人爱 | 亚洲V欧美中日韩 | 手机亚洲视频在线观看 | 好男人社区www在线资源视频 | 欧美性一交一乱一伦 | 精品国产亚洲午夜精品av99 | 国产专区欧美专区日韩专区 | 亚洲天堂看电影无码 | 日本天堂中文字幕有码 | 无码一区二区三区少妇精品 | 亚洲国产欧美日韩在线 | 国产三级自拍亚洲成人自拍 | 色情版巜劳拉性放荡id剧情 | 日本一区二区欧美日韩 | 激情A∨无遮挡在线看 | 亚洲欧美日韩在线观看你懂的 | 不卡无码在一区二区三区四区 | 性xxxx歐美老婦胖老太性多毛 | 男女做爰猛烈啪啪高潮漫画 | 天天躁夜夜躁狠狠躁综合真实 | 女人真人毛片全免费看 | 午夜蜜桃av精品影院无码小说 | 成人免费观看的av网站 | 免费国产高清看片 | 亚洲精品视频在线观看免费 | 国产系列久久影院 | 国产精品日本亚洲77 | toilet厕所撒尿偷窥pissing | 强奷有码在线播放 | 久久精品高清视频一区二区 | 久久夜色精品国产小说 | 欧美性精品日韩在线 | 亚洲精品AⅤ无码精品丝袜无码 | 无码的免费的毛片视频日韩 | 色欲视频一区二区三区在线观看 | 亚洲中文字幕无码久久2017 | jiZZ成熟丰满女人少妇直播 | 国产精品美女在线专区 | 福利一区二区三区在线观看国产 | 日韩无码中字一二三区 | 久久国产精品亚洲精品亚洲精品 | 最好高清视频在线观看 | 欧美熟妇另类久久综合资源 | 色窝窝无码一区二区三区成人网站... | japanesexxxx日本熟妇伦视频 | 婷婷悠悠色悠在线播放 | 尤物精品国产第一福利三区 | 成人在线三级毛片免费看 | 98视频精品全国免费观看 | 精品国产亚洲人成在线观看芒果 | 看黄色三级片男人插女人逼视频 | igao午夜在线视频播放 | 国产三级黄色av | 国产精品午夜福利电影 | 日韩a∨无码一区二区三区不卡 | 亚洲综合中文字幕av | 伊人亚洲精品熟女 | 在办公室拨开老师内裤进入 | 婷婷悠悠色悠在线播放 | 全色黄大片一级AAA片PC | 亚洲系列av无码av一区麻豆 | 男人把女人桶到爽免费看视频 | 三级视频欧美不卡在线观看 | 人妻精品久久久久 | 日韩专区在线观看视频 | 自慰少妇裸体无码30p | 日韩高清一区在线观看 | 久久精品视频免费观看视频 | 91大帝国产紫薇高潮 | 成人精品玖玖资源在线播放 | 国产乱妇无码大片在线观看免费 | 亚洲r成人av久久人人爽 | 亚洲欧美成年a级片 | 亚洲国产综合精品中文第99 | 亚洲AV日韩AV国内 | 城中村嫖妓丰满少妇 | 国产无码在线第一页 | 国产福利一区二区精品视频麻豆 | 粉嫩小仙女扒开自慰喷水图片 | 9420免费高清在线观看1 | 好看的久久黄网站 | 无码成人片一区二区三区 | 欧美一级韩国一级日韩一级 | 午夜欧美一区二区三免费观看 | 99日本一区二区 | 影音先锋金发性爱 | 国产午夜精品1区2区3区 | 国产97超碰人人做人人爱 | 亚洲国产欧美在线看片一国产 | 日韩看片自拍视频在线观看网站 | 殴美国产中文字幕视频在线观看 | 99国产网红主播在线影院 | 亚洲自偷自偷制服丝袜图片 | 日韩欧美一级a不卡 | 69精品久久久久久久久久久国产 | 视频一区二区村上凉子 | 日韩精品在线网站 | 国产A级久久久精品毛片 | 好男人社区www在线资源视频 | 无遮挡啪啪网站免费观看 | 国产精品一区二区三区视频观看 | 黄色无码视频在线看 | 久久久亚洲精品好片 | 台湾精品视频在线看 | 亚洲欧美综合另类天堂网 | 日本免费高清一本大道一区 | 国产中文字幕在线播放 | rosi丝袜大胆福利视频邦女郎 | 久久91精品国产91久久戶 | 男女国产精品久久久 | 放荡的三级护士国产精品主播 | 人妻无码久久影视 | 午夜免费精品久久久 | 香蕉久久丫精品忘忧草产品 | 欧美残虐另类xxxxⅹoooo | 国产无套粉嫩白浆 | 三级黄色一区二区 | 99热最新免费获取网址 | 加勒比av高清无码下载 | 国产重口另类精品无码av免费 | 国产在线观看精品一区二区 | 久久刺激cijilu福利一区 | 制服丝袜自拍另类第1页 | 日韩高清的天堂在线观看免费 | 网站有海量精选视频→日韩日韩日韩日韩精品 | 国产成人久久综合777777麻豆 | 婷婷97狠狠的狠狠的爱 | 青青久在线视频首页 | 青青草原无码视频 | 欧美国产一级特黄AAA大片在线观看 | 饥渴老熟妇乱子在线播放 | 最新国产在线观看福利91 | 99久久精品少妇高潮喷水 | 亚洲国产欧美另类刺激在线 | 欧美日韩激情 | japanese国产在线播放 | 国产av自拍人人操 | 日本视频免费高清一本14 | 3344成年在线视频免费下载 | 亚洲成年一区二区三区 | 最近中文字幕MV免费高清动漫 | 拍拍拍交性免费视频 | 岁欧美乱子伦xxxx | 精品国产三级大片网址 | 国产精品无码a v久 | 原创国产第一页AV日韩高清在线 | 免费很黄很污的软件下载 | 伊人精品无码精品网站 | 亚洲熟妇无码A∨在线直播 | 永久免费av片在线观看全网站 | 99久久精品蜜臀色欲 | 欧美少妇综合中文 | 日本视频在线观看一区二区三区 | 国产极品粉嫩馒头一线天图片 | 一区二区制服丝袜 | 神马影院亚洲夫妻在线观看 | 精品一区二区波多野结衣 | 老男人久久青草AV | 亚洲性爱第一页 | 真人作爱90分钟免费看视频 | 翁含着我的奶边摸边做小视频 | 2021国产自一区二区芒果 | 國產69精品久久久久9999縣 | 人妻少妇被粗大爽电影 | 国产呦交精品免费视频无码 | 免费无码一区二区三区A片百度 | 24小时更新在线观看片 | 網友分享91av视频心得 | 在线播放连续内射爽翻天vol | 日产一区二区在线 欧洲 | 桃红色世界最快永久2023 | 亚洲欧美日本国产专区一区全集 | 亚洲Aⅴ福利天堂导导航 | 亚洲最新国产美女在线观看 | 欧州一区二区无码精品片免费不卡 | 国产 欧美 日韩 综合久久 | 国产白浆一区二区三区视频在线 | 免费试看午夜福利视频 | 一本色道无码DVD中文字幕 | 人操在线视频 | 久久视频在线视频精品 | 亚洲精品国产vⒶ在线观看 | 丁香色狠狠色综合久久 | 亚洲精品视频免费 | 蜜桃视频在线影院入口在线观看 | 国产69堂高清精品 | 另类 专区 欧美 制服丝袜 | 亚洲AV无限制福利在线 | 欧美成人a级视频免费 | 亚洲无码手机在线 | 色婷婷中文字幕 | 久久综合色鬼久久88中文 | 99久久久久国产精品免费 | 亚洲成人国产资源 | 國產又黃又色又粗又大又長 | 性xxxx歐美老婦胖老太性多毛 | 精品一区二区波多野结衣 | 日韩少妇人妻无码精品网 | 榴莲APP榴莲色榴莲18岁 | 色琪琪永久免费观看视频 | 亲嘴揉胸口激烈视频 | 入侵人妻反抗中文字幕 | 97人妻人人做人碰人人爽流奶水 | 国产高清免费一级视频播放在线观看 | 免费网站在线观看人数在哪动漫 | 韩国美女内部亚洲一区视频 | 日产一区二区三区精品视频在线 | 午夜国产高清在线 | 免费一级a毛片在线视频播放 | 小雪被老汉各种姿势玩 | 苍井空无码av丁香五月 | 梦乃爱华作品在线观看播放 | 国产精品人妻久久毛片一 | 三級中文字幕電影大全 | 边做饭边被躁我和邻居视频 | 国产熟睡乱子伦a片国产一级视频播放 | 国产超碰在线观看 | 日韩大片免费在线观看 | 菠萝蜜麻豆一区 | 午夜福利视频91 | 香蕉视频在线观看入口 | 国产aa免费一级视频 | 久久91精品国产91久久戶 | 国产在线精品亚洲二线 | 国产一级AAA精品免费看 | 美女日p国产在线观看 | 亚洲日本vÄ中文字幕久久 | 日韩免费视频片源丰富、内容全面 | 免費無碼成人AV在線播 | 亚洲三级二区亚洲欧洲综合 | 98久久人妻少妇激情啪啪 | 成人免费观看的av网站 | 成人毛片一级在线播放 | 国产女子牲交免费视频视频 | 国产精品免费人成网站等最新內容 | 性欧美日韩国产XXXXX视频 | 日韩一品欧美一区 | 中文字幕日本熟女视频高清 | 日韩黄色小说 | 亚洲乱码中文字幕综合久久久 | 国产成人αV无码专区亚洲αV | 乳欲の馆~无删减在线观看 | 久久国产成人亚洲精品影院老金 | 亞洲日韓成人av無碼網站 | 美女国产欧美日韩 | 无码aⅴ无码天堂资源网z | 国产在线观看免费观看不卡 | 国产情趣免费视频在线观看 | 午夜国产欧美 | 伊人网一本三区五月婷婷伊人久 | 亚洲av色区在线播放 | 国产精品99久久久久久人夜夜嗨 | 中文精品日韩成人欧美 | 国产午夜成人免费一区 | 亚洲一区高跟丝袜秘书自慰 | mav影视视频网站 | 欧美性爱综合网站99国品区区视频 | 国产98堂在线视频 | 变态调教一区二区三区 | 区一区二国产精品 | 欧美成综合一区在线观看 | 国产一级毛一级毛片 | 女人毛多水多的视频 | 24小时国产综合成人久久大片91 | 日本在线高清不卡一区二区 | 人八碰人人爱免费 | 精品欧洲无码一区二区三区 | 护士奶头又大又软又好摸 | 久久精品久久久久久不卡免费观看 | 国产最黄最黄的裸片小视频免费看 | 欧美亚洲国产精品久久 | 26uuu国产在线精品一区二区 | 久久久精品网站无码 | 成人一区二区精品在线 | av中文字幕精品一区二区久久久 | 日韩在线一区奇米影视777在线精品 | 姝姝窝人体色www国产 | 欧美在线日韩在线国产在线 | 三上悠亚激情av一区二区三区 | 国产91欧美成人免费观看 | 成年黄污无遮挡无码网站 | 四川少妇搡BBB搡BBB爽爽爽小说 | 激情无码专区在线观看 | 伊人网视频人成在线 | 国产欧洲av网站 | 无码精品国产av | 成人精品电影一区二区三区 | 日韩a∨无码一区二区三区不卡 | 久久久成人影院 | 精品调教一区二区三区 | 777久久婷婷成人综合色 | 久久精品只有这里有 | 亚洲色欧美国产综合 | 香港奇案之屯门色魔 | 精品无码无人网站免费 | 亚洲一区二区三区国产欧美 | 惠民福利国产高潮抽搐喷水高清 | 亚洲综合日韩a无码毛片 | 人妻av中文系列制服丝袜 | 亚洲精品国产精品自产中幕字幕 | 国精品无码一区二区三区在线蜜 | 亚洲一区天堂 | 無碼人妻αⅤ免費一區二區三區 | 寂寞少妇挑战18厘米黑人 | 无毒不卡在线播放 | 亚洲av秘 精品久久不卡 | 视频一区二区三区在线免费 | 伦理亚洲一区二区 | 热の无码综合 视频二区 | 欧美亚州日本 | 波多野结衣在线观看网址 | 日韩成人影视一区二区中文字幕 | 久久精品亚洲欧美成人影院 | 色情版巜劳拉性放荡id剧情 | 中文字幕乱码无限2021 | 男女做爰猛烈啪啪高潮漫画 | 天天影视久久综合综合久久 | 欧美成人影院免费观 | 亚洲自慰一区二区 | 日韩国产中文字幕不卡视频 | 亚洲国产欧美另类一区二区 | 高跟丝袜熟女国产一区 | 国产日产精品久久久久久婷婷 | 91精品国产综合久久久 | 中文字幕一区二区5566在线 | 在线高清中国videossexo | 天堂最新版在线网www | 国产精品欧洲专区无码 | www免费视频在线观看播放 | 亚洲国产成人国产尤物在线播放 | 日韩一区二区三区四区五区 | 国产精品香蕉成人网在线观看 | avAV一区二区三区在线 | 黄色片久久美女啊啊啊内色 | 国产91精品一区二区色情男男 | 嘟嘟丰满久久久尤物5566高清 | 熟女精品Va中文字幕 | 亚洲AV成人无码网站18禁网址 | 婷婷久久人人爽人人爽 | 国产午夜福利电影欧美日韩 | 亚洲欧美另类久久精品 | 人妻碰碰人妻碰碰 | 久久久精品人妻一区二区三区四区 | 欧美亚洲韩日国产 | 无码aⅴ无码天堂资源网z | 亚洲成ä人片在线观看网 | 欧美残虐另类xxxxⅹoooo | 国产精品无码22页 | 資源狠狠色婷婷久久一区二区同步更新 | 动漫男生女生在一起嗟嗟嗟 | 精品亚洲欧美大片 | 久久刺激cijilu福利一区 | yellow中文字幕熟女 | 欧美妇性猛交视频 | 中文字幕日美韩专场 | 色欲色欲日韩www在线观看 | 欧美国产亚洲日韩在线高清二区 | 黄色成人性爱电影在线观看网 | 中国大成色www永久网站 | 国产一级变态a视频 | 116美女写真视频手机游戏 | 一区二区三区国产午夜福利 | 亚洲成av人片无码 | a级国产大片在线免费观看 | 日韩中出在线一区二区人妻 | 日韩无砖专区一中文字目码在线视频最新 | 国产精品自产拍在线观看更新 | 亚洲综合精品日韩欧美在线一区 | 韩国一区二区三免费看在线高清 | 午夜无码人妻AⅤ大片色欲张柏芝 | 国产刺激视频在线观看 | 入侵人妻反抗中文字幕 | 国产精品制服丝袜另类一区 | 人妻无码一区二区三区不卡 | 国产女子牲交免费视频视频 | 18禁无遮挡啪啪无码网站 | 91页国产在线自啪 | 成年女人看片免费视频74 | 国产高清在线精品一区app | a级国产大片在线免费观看 | (愛妃)亚洲AV无码专区在线播放中文 | 日本无码av一区二区三区 | 无码毛片高潮一级一级喷水黑人 | 苍井空中文字幕在线观看 | 加勒比高清无码二区在线三级免费电影dvd | 日本WWW色欧美美女性爱视频 | 影音资源在线观看 | 翁含着我的奶边摸边做小视频 | 亚洲伊人久久大香线焦 | 男女啪啪啪猛烈无遮挡 | 亚洲欧洲美洲无码精品Va水蜜桃 | 四虎国产精品免费观看 | 女人自慰全过程免费看 | 欧美成人免费二区电影 | 亚洲少妇三级片网站在线观看免费 | 国产精品 十八爽爽爽 | 丁香五月天婷婷国产精品 | 在线综合亚洲欧美青青 | 亚洲精品日韩片无码中文字幕一级免费 | 亚洲有码在线视频 | 国产在线视频直播 | 久久精品国产亚洲āV蜜臀色欲一级毛片 | 中文字幕在线欧美日韩在线播放 | 日韩激情在线视频观看 | 好吊视频欧美国产在线观看 | 在线国自偷图片亚洲 | 亚洲精品另类中文 | 国产亚洲欧美电影在线观看 | 麻豆aⅴ精品无码一区二区 | 51久久国产露脸精品国产 | 亚洲人妻日韩欧洲中文字幕 | 国产一级黄片在线免费观看 | 人妻侵犯久久久影院 | 色综合色欲色综合一区 | 五月天在线视频国产在线一 | 3atv国产精品视频 | 2012中文字幕电影 | 99久久久国语露脸精品国产麻豆 | 久久综合国产91久久精品 | 长靴调教在线播放国产 | 久久久久久精品精品免费 | 妖精动漫免费登录入口今日知乎 | 18成禁人看免费无遮挡在线观看 | 色欲视频一区二区三区在线观看 | 欧洲 日韩中文无码视频 | 国产啊v在线看免费播放 | 国产高清吃奶成免费视频网站 | 日本WWW色欧美美女性爱视频 | 国产在线观看人成激情视频 | 国产xxxx视频免费播放 | 黄色小电影在线免费观看 | 杨贵妃颤抖双乳呻吟求欢电影 | 日韩在线一区奇米影视777在线精品 | 亚洲一区二区在线观看中文字幕 | 少妇内射高潮福利炮 | 亚洲AV秘无码不卡在线观看 | 免费看污的全亚洲网站 | 护士交换配乱吟粗大交换配 | 日韩美女精品视频网站 | 高清无码精品综合一区二区三区色片 | 亚洲av乱码国产 | 日韩精品三级一区二区三区 | 99国产一区二区精品久久呦 | 国产一区二区三区在线观看免费 | 日韩专区无码专区 | 亚洲一区天堂 | 久久精品国产亚洲7777 | 99草在线视频这里只有精品 | 男女18禁啪啪无遮挡免费视看 | 在线亚洲欧洲日产一区2区 | 亚洲国产综合精品中文第99 | 成人免費觀看www視頻 | 婷婷天堂综合视频 | 国产人成精品免费久久久 | Jizz国产精品护士日本国产 | 日本少婦比比中文字幕 | 亚洲无码性爱视频网站 | 欧美色交五月天丁香综合 | 美熟妇办公室撞击浪吟娇喘 | 99久久精品国产一区二区三区色 | 色多网站在线观看 | 国产在线播放第16页 | 久久久高潮免费流白浆 | 国内自拍视频在线观看 | 久久综合国产91久久精品 | 深夜福利在线APP | 尤物视频在线看 | 日韩大片免费在线观看 | 欧美情se国产在线视频 | 日韩一区二区三区在线观看不卡 | 中国国产成人精品久久 | 国产成人精品一区二三区 | 未成满18禁片无遮挡观看 | 亚洲愉拍自拍视频一区不卡 | 亚洲性爱精品视频 | 可以在线观看的黄色网址 | 欧美日韩精品久久久免费观看 | 九九99热久久精品66中文字幕 | 亚洲一区二区三区不卡无码 | 国产一区二区三区威久国际 | 美丽的熟妇中文字幕 | 韩国欧洲一级毛片免费 | 一道本二区视频不卡 | 香蕉视频在线观看成人app | 三级黄色网址 | 亚洲人AV片在线无码影院观看 | 波多野结衣少妇人妻内射 | 久久久成人影院 | 亚洲AV无码乱码国产精品免费 | 日韩少妇人妻无码精品网 | 美日韩无码高清一区二区三区 | 两对夫妇交换配偶过夜 | 亚洲精品视频在线观看免费 | 96久久夜色精品国产九色杨思敏 | 嫩草视频观看精品伊人 | 日产日韩久久影院 | 日韩精品中文字幕资源在线 | 欧美日韩国产综合一区二区三区 | 大学生高清一级毛片免费 | 中文字幕αⅴ无码高青在线 | 久久久成人影院 | 国产极品精品婷婷久久精品 | 久久久无码国产精品免费 | 欧美字幕第一页 | 国产国语对白激情视频 | 6080yy久久亚洲日本不卡 | 不卡无码在一区二区三区四区 | 无码aⅴ无码天堂资源网z | 午夜性色福利视频久久 | 久久久久亚洲麻豆 | 一区二区三区高清视频大全 | 亚洲AV无码国产精品色午夜久久 | 国内精品永久av免费看 | 亚洲AV无码国产乱色欲 | 公天天吃我奶躁我的 | 成人免费观看的av网站 | 中文字幕在文字幕乱码一二三 | 99热99这里有免费精品 | 下载黄片软件 | 国产一区二区三区精品蜜臀 | 黑人又粗又大一区二区 | 欧美成人一区在线 | 99精品黄片免费看 | 色综合五月天 | 小h片资源免费观看在线 | 日韩在线一区奇米影视777在线精品 | 十八禁羞羞视频爽爽爽 | 亚洲精品日韩在线91 | 在线高清中国videossexo | 国产一级在视频在线观 | 手机影院国产色片 | 午夜欧美精品久久久久久懂色 | 亚洲AV无码一区二区三区看 | 国产未成女一区二区在 | 日韩国产中文三区 | 偷自拍亚洲欧美一区二页 | 蜜桃视频在线影院入口在线观看 | 欧美老熟妇乱大交XXXXX | 久产久精国产大片 | 一区二区三区国产午夜福利 | 高清一级a爱免费视频 | 波多野结衣高清久久一区 | 国产成+人+综合+欧美 亚洲 | 国产av巨作搭讪美女8 | 久久精品色妇熟妇丰满人妻3p | 五月天婷婷综合网 | 亚洲精品国产AⅤ综合第一己 | 亞洲國產精品一區二區www' | 亚洲成ä人片在线观看网 | 91福利在线精品国产 | 三级理论电影三级午夜电影院 | 亚洲人成网77777色在线播放 | 成人在线播放视频免费 | 久久国产精品福利一区二区三区 | 日韩亚洲欧美视频一区 | 久久精品只有这里有 | 91传媒制片厂app官方网址 | 亚洲a∨永久无码精品秋霞电影影院 | 荷兰妓女丰满大乳大屁股bbw | 馆熟女后编H动漫 | 亚洲 中文 字幕视频天堂 | 草b视频在线观看 | 国产国产人免费人成免费视频下载 | 亚洲无码一区盗摄土豆 | 伊人久久大香线蕉网精品 | 久久精品国产一区二区暴力 | 一级特黄牲大片免费视频 | 国产精品视频一区国模私拍丝袜 | 2019国自产拍免费 | 国产日本高清一区 | 国产成人αV无码专区亚洲αV | 国产馆av大片免费 | 在线日韩成人电视播放网站视频免费 | 久久久成人影院 | 日韩高清一区在线观看 | 思思久99在热国产丝袜美女一区二区三区 | 亚洲av中文无码4区免费 | 日韩人妻无码αⅤ中文字幕 | 国产人妻黑人一区二区三区 | 免费观看亚洲精品国产成人99久久 | 自拍户外精品a视频在线观看 | 欧美日韩国产一级久久忘忧草 | 美女隐私秘视频黄www曰本 | 东北50老熟女日出白浆视频 | 中文字幕无码免费2020 | 亚洲a∨高清激情一区成熟一级毛片 | 国产男男制服AV在线 | 国产又色又刺激高潮免费看 | 欧美三级福利片 | 在线日韩成人电视播放网站视频免费 | 欧美一级a做视频免费 | 亚洲精品中文字幕无乱码麻豆 | 亚洲电影+有码+中文字幕 | 久久久久亚洲av成人篇小说 | 香蕉视频黄色下载 | 变态调教一区二区三区 | 1024看片欧美xxapp高清 | 亚洲精品乱码久久久久久自慰国产卡一卡二无线乱码 | 亞洲國產精品無碼久久98 | 无码人妻一区二区三区九色 | 中文美女乱婬试看视频 | 成人一级黄色片免费看 | 91绿帽绿奴在线观看 | 一区二区三区国产大片 | 欧美a一级特黄大片 | 日本一区二区三区免费网址 | 亚洲av无码偷拍在线观看 | 7878国产不卡视频 | 国产色欲婬乱免费视频视频 | 爽爽无码18禁免费国产 | 精品蜜臀久久久久97网站 | 星巴克app破解版免费下载 | 国产精品午夜福利小视频合集 | 福利姬国产在线观看免费 | 亚洲色偷偷男人的天堂 | 欧美牲交视频免费观看 | 一区二区三区久久久久久久久 | 国产又粗又大又爽又免费色网视频 | 一級做a爰視頻免費觀看2019 | 无码日韩做暖暖大全免费久久 | 国产精品高清在线xxx | 一区二区三区国产大片 | 成人免费无码视频在线直播 | 久久久久一区二区三区四区 | 囯产亚州欧类另类另 | 好深好湿好硬顶到了好爽H动态图 | 精东影业jdmy国产 | 中文字幕亚洲一区二区乱码熟女 | 在线日韩成人电视播放网站视频免费 | 97超级碰碰碰久久久久总站 | 久久亚洲欧美视频1025 | 欧美日韩一区二区三区不卡在线观看 | 福利精品国产自产在线 | 黄色小电影在线免费观看 | 欧美一极大片免费 | 久久这里只精品国产18 | 亚洲AV永久无码精品网站亚洲综合色区在线观看 | 97午夜理伦影院在线观看 | 一区二区三区免费视频不卡 | 久久国产精品亚洲天堂 | 亚洲成人av一二区 | 惠民福利国产在线精彩视频二区 | 欧美一卡二卡3卡4卡无卡免费 | 99re6免费视频 这里只有精品 | av中文字幕精品一区二区久久久 | 日本二区久久噜噜 | 欧美爆乳熟妇喷水视频免费 | 一本大道在线播放天天 | 成全视频在线观看免费播放 | 人人澡人人爽 | 日韩中文有码在线 | 伊人乱伦中文字幕一区二区三区四区 | 国模私拍精品一区二区 | 国产精品视频一区国模私拍丝袜 | 国产又粗又大又爽又免费色网视频 | 91看片无码视频第40页 | 国产a毛片高清视频日日愛 | 婷婷久久人人爽人人爽 | 国产美女一区二区三区四区 | 殴美国产中文字幕视频在线观看 | 伊人久久大香线蕉一区 | 女人隐私部位免费全部久久久一区二区 | 可以看的免费黄色网址 | 欧美国产精品伦一区二区免费天天精品国产 | 久久久无码免费毛片色欲av | 欧美日韩成人综合国产 | 日本不卡中文字幕一区二区三区 | 中文字幕日本熟女视频高清 | 古代全部一级毛片在线完整版 | 欧美日韩激情在线一区 | 狠狠狠色7777综合久夜色撩人 | 91精品国产日韩91久久久久久 | 99九九精品视频 | 任你躁在线精品视频m3u8 | 亚洲精品福利精品视频 | 中文字幕亚洲手机在线视频 | 看片中文字幕一区二区 | 日本在线一区三区国产主播 | 欧美大黄永久免费播放 | 国产日韩欧美亚州精品中字95 | 久久亚洲欧美视频1025 | 久久久精品人妻一区二区三区四区 | 成人无码网站在线免费观看 | 一女被男玩l喷潮视频免费 | 国产免费Av福利在线吧 | 午夜精品视频在线看 | 老师大爆乳双腿张开自慰喷水 | 国产一级簧片 | 国产日韩欧美丝袜一区二区 | 亚洲成人av在线天堂 | 大香蕉太香蕉成人现现 | 黄色国产色在线剧情 | 久久精品蜜芽亚洲国产AV无码 | 天天操夜夜操人人操 | 丝袜制服自拍欧美亚洲 | 18禁止美女爆乳免费网站 | 91丨91poNY丨国产入口 | 日韩 福利 在线视频播放 | 国产日产在线不卡省流观看 | 黄色在线免费观看视频 | 日韩秋霞电影在线视频观看 | 亚洲国产成人国产尤物在线播放 | 波多野结衣办公室33分钟激情 | 免费综合中文自拍 | 久久人人精品一区二区 | 亚洲日韩a¢¥在线视频 | 城中村嫖妓丰满少妇 | 欧美爆乳熟妇喷水视频免费 | AV高清毛片免费 | 午夜视频在线观看一区二区福利 | 免费一区亚洲热香蕉有码 | 嗯~乖自己摇H尿出来 | 亚洲国产中文成人九九综合 | 中文精品日韩成人欧美 | 97se亚洲综合在线天天 | 青柠影院日韩一三区 | 国产高清啪啪免费视频 | 2021国产精品卡一卡二卡三 | 欧美日韩午夜高清无码一级片 | 精品高清久久三级 | 亚洲网免费视频在线观看 | 国产在线观看精品一区二区 | 午夜av亚洲一码二中文字幕青青 | 三区美女视频在线观看 | 国产微拍短视频迅雷下载 | 亚洲欧美日韩国产精品第不页 | 国产精品无码不卡午夜 | 任你懆视频这精品2019 | 亚洲vodafone精品性 | 欧美黑人巨大在线 | 真人做爰高潮免费观看 | 一区二区三区熟女少妇视频. | 午夜理伦三级在线观看 | 殴美国产中文字幕视频在线观看 | 极品尤物美女一区二区三区 | 午夜免费成人大片 | 在线高清中国videossexo | 日本一区欧美激情在线观看 | 日本最大色倩网站www不卡 | 国产极品尤物av一区在线观看 | 橘子视频成免费人在线观看 | 日韩高清乱码在线观看 | 久久中文字幕网站深田咏美 | 男女成人秒免费试看久久 | 午夜福利精品一区二区在线 | 伊人狠狠色丁香婷婷 | 国产精品sss在线观看av | 蜜桃视频免费 | 打飞专用的熟妇图片66p | 国产最黄最黄的裸片小视频免费看 | 国产三级片视频播放 | 热综合一本伊人久久精品网址 | 久久久久琪琪精品色 | 欧美疯狂做受XXX高潮 | 无码gogo大胆啪啪艺术8523 | 一级无 码在线观看 | 毛片免费久久久久 | 国产亚洲成人网站在线观看 | 欧美另类亚洲一区二区 | 亚洲天堂无码av在线天堂 | 亚洲欧美综合茄子 | 性色免费视频观看 | 午夜福利在线第一 | 高清不卡免费直播毛片 | (愛妃)亚洲AV无码专区在线播放中文 | 亚洲欧洲精品无码一区二区夜夜嗨 | 青草草草草在线视频 | 无码äV综合网国产精品 | av在线天堂网自拍 | 国产精品1204永久免费视频 | 亚洲成Aⅴ人在线观看影院 | 三区美女视频在线观看 | 小莹的性荡生活45章最新章节 | 国产a毛片高清视频日日愛 | 高清女女同性一区二区 | 现在精品视频一区二区 | 国产精品99久久久久久人夜夜嗨 | 免费福利成人影院 | 亚洲第一欧美国产 | 香蕉视频黄色下载 | 91精品国久久久久久无码免费 | 久久精品亚洲乱码 | 国产a三级AV最新免费黄色网址 | 亚洲AV综合色区国产精品天天 | 国产v亚洲v欧美v专区 | 给我免费播放片在线中国 | 国产精品一级片在线播放 | 久久久久国产一级毛片高清牌 | 邻居勃起人妻忍不住中文字幕 | 天堂在线男人天堂 | 久草在线在线精品观看99 | 免337p日本欧洲亚洲大胆色噜噜 | 欧美视频一区高清不卡 | 国产福利一区二区精品视频麻豆 | 男女激情自拍全裸免费看 | 一级做a视频久久久免费 | 一个人免费日韩不卡视频 | 嗯~乖自己摇H尿出来 | 久久久无码国产精品免费 | 糖心logo官方网站在线观看 | 伊人久久大香线蕉无码不卡亚洲 | 国产精品国产精品国产精品 | 成人免费网站久久久 | 亚洲成人高清在线 | 18AV视频在线观看 | 在线乱码一卡二卡麻豆 | 影视八戒影视久久精品国产 | 久久精品欧美日韩精品不卡 | 韩漫无羞遮漫画免费漫画 | 亚洲精品高清女同中文字幕 | 亚洲一区二区三区不卡无码 | 91偷拍裸体一区二区三区 | 亚洲精品日韩片无码中文字幕一级免费 | 女人的奶头(无遮掩)视频 | 午夜免费视频国产在线观看 | 日本熟妇人妖体內射精 | 涩涩涩视频在线观看免费 | 四季亚洲AV无码一区二区三匹在线观看 | 黑土ち部下腿法娴熟 | 99热久久视频只有精品在线 | 日韩国产一区二区无码av | 男人把女人桶到爽免费看视频 | 中国大成色www永久网站 | 国产午夜精品福利久久网站 | 国产一区二区美女自卫 | 丁香婷婷五月综合激情 | 国产视频搜索在线直播 | 欧美老熟妇乱大交XXXXX | 国产zw在线一区 | 国产专区一线二线三线码 | 粉色视频污版APP下载 | 亚洲中文字幕一区二区荷花一本一道 | 青青草原精品资源站久久 | 国产免费综合色视频 | 韩国亚洲精品A在线无码 | 在线观看高清黄网站免费视频 | 亚洲欧洲成人一区二区三区 | 亚洲人成影院在线观看 | 国产高清精品自在线看 | 国产一区二区美女自卫 | 久久久精品一本二本三本 | 久久久高校女厕所偷拍视频 | 秋霞理论理论福利片 | 精品国产乱码久久久呢 | 蜜桃视频在线影院入口在线观看 | 制服无码第一页在线 | 国无码精油按摩在线直播 | 久久99国产麻豆一区二区三区网站 | 欧美一卡二卡3卡4卡无卡免费 | 久久天天躁狠狠躁夜夜97 | 在线 亚洲 校园 在线 无码 | 99久9久免费国产动漫 | 国产玩肛门视频迅雷下载 | 精品无码一区二区三区爱欲小说 | 欧美日韩精品一区不卡福利一四级在线 | 午夜亚洲福利av | 污片无码在线影院浪潮AV | 性色av免费毛片一区二区 | 国产又湿又大又硬网站视频 | 国产一区二区波多野结衣在线看 | 亚洲成Aⅴ人在线观看影院 | 成·人免费午夜无码视频在线观 | 欧美午夜成午夜成年片在线观看 | 巨大乳首に揉んで乳搾り | 制服无码第一页在线 | 亚洲二区亚洲国产综合专区在线电影 | 日韩美女免费毛片 | 国产精品无码不卡午夜 | 亚洲日本中文字幕电影 | 97人人模人人爽视频一区二区 | 久草色香视频在线观看 | 韩国美女内部亚洲一区视频 | 香蕉禁止视频免费看 | 夜夜揉揉日日人人视频 | 精品人妻毛片久久久久久 | 国产a三级AV最新免费黄色网址 | 国产毛片精品高清一区二区 | 91短视频在线观看经典下载 | 99久久國產熱無碼精品免費 | 国产成人毛片无码视频1080P | 新sss亚洲视频一区手机版 | 美国超碰欧美妇乱 | 亚洲日本中文字幕电影 | 亚洲特黄一区无码 | 青青在线精品2018国产 | 欧美透逼视频 | 欧美欧美二区毛大片 | 久久综合香蕉网eeuss | 亚洲AV综合色区无码三区偷拍 | 久久国产自产亚洲天堂 | 韩国Ⅴ日本V欧美V | 欧美亚洲另类精品精品一区 |